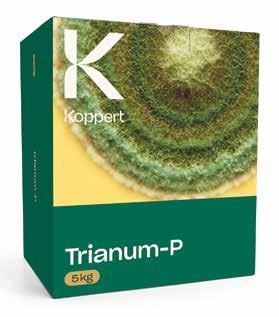

Nº 202• Octubre 2025



![]()

Nº 202• Octubre 2025



Las altas temperaturas favorecen la proliferación de la araña roja y el Thrips parvispinus y afecta al desarrollo de las plantas, que dejan de lado los cuajes para centrarse en su propio crecimiento

45 | BASF construye su finca experimental en el Cortijo Quesada y traslada su sede social a El Ejido
| Roquetas de Mar acuerda suministrar agua regenerada de la EDAR para riego agrícola







BASF|Nunhems iniciará en enero la construcción de Almex, su nueva estación experimental y sede que se levantará en las 25 hectáreas que ocupaba el antiguo cortijo Quesada de El Ejido. La empresa apuesta así de forma decidida por la provincia para continuar desarrollando su negocio a nivel global. /A. FERNÁNDEZ

Actualidad Editorial

Se ha cumplido un año de la desastrosa Dana que tantos daños causó a miles de ciudadanos en El Ejido. Invernaderos rotos, cosechas destrozadas y cientos de coches afectados por el impacto de granizos de hielo del tamaño de bolas de golf. Hace un año se puso de manifiesto que el Poniente almeriense corre un serio peligro en caso de que se produzcan fuertes precipitaciones como las que estamos viendo en diferentes puntos de España y en cualquier parte de la geografía mundial. Tormentas que arrojen 200 ó 300 litros de agua en un corto espacio de tiempo, que ahora son comunes, podrían dejar una enorme huella negativa en cualquier punto de esta gran zona agrícola provincial.
Todo esto se sabe desde hace mucho tiempo y el año pasado vivimos un aviso de lo que puede ser un de -
sastre natural provocado por esas intensas lluvias que se producen cuando acaba el verano. No obstante, lo peor de todo es que en el periodo de un año nadie ha hecho nada, ni nadie ha comunicado que se esté haciendo algo para poder evitar un desastre que se puede presentar en cualquier momento. La estructura física del territorio en el Poniente almeriense revela el enorme peligro que hay en muchos puntos de la geografía local la Sierra de Gádor con 86.000 hectáreas de las que 30.000 dan su cara al sur que está labrada de ramblas que envían toda su agua a un Valle cuya parte más profunda es la Balsa del Sapo en Las Norias y de ahí su salida natural es por Los Bajos en Roquetas de Mar, donde se encuentra la plaza de toros de este municipio. Desde Balerma no hay ninguna salida natural directa en todo el Poniente que con-
duzca el agua desde la sierra hasta el mar Mediterráneo, allí la Rambla del Loco sí evacua escorrentías procedentes del entorno y de Dalías. También es cierto que hay otra salida natural en Balanegra que conecta la montaña directamente con el Mediterráneo, pero salvando estas dos salidas todas las demás ramblas como son El Águila, Los Moneros, La Maleza, Carcáuz y otras muchas más vierten el agua en dirección a la vaguada que hay desde El Ejido hasta Roquetas pasando por Las Norias y La Mojonera. Cabe preguntarse si el estado actual de esas salidas naturales del agua es el idóneo para que no se produzcan situaciones que no puedan ser controladas por el hombre. Cabe preguntarse si los cauces están debidamente respetados, si la limpieza de los mismos es la adecuada y si las salidas previstas tienen capacidad para
evacuar importantes cantidades de lluvia en un corto espacio de tiempo. Sin ir más lejos la Rambla del Águila, una de las más importantes que hay en el Poniente almeriense por la cantidad de agua que puede recoger en su origen en el corazón de la Sierra de Gádor, sufre una perturbación visible a la altura de la Cooperativa Santa María del Águila, dónde su caudal se reduce a un leve canal que no podría absorber importantes cantidades en caso de que se produjera una Dana. Lo mismo que en esta rambla hay otras cuya situación es parecida y las posibilidades de que se produzca el desastre son notables. Sirva esta advertencia para que aquellos que tienen que idear medidas de prevención lo hagan con urgencia porque no podemos estar todos los años por esta fecha mirando al cielo un día sí y otro también.
Las altas temperaturas favorecen la proliferación de la araña roja y el Thrips parvispinus y afecta al desarrollo de las plantas, que dejan de lado los cuajes para centrarse en su propio crecimiento
tán yendo a la altura del pecho y de la boca, es una escabechina”.
El frío no quiere llegar a la provincia de Almería. Durante este mes de octubre, puntos como El Ejido, Campohermoso, Vera o Aguadulce, entre otros, han alcanzado o incluso superado los 30 grados centígrados, una situación que trae de cabeza a los agricultores y técnicos almerienses por el avance de plagas como la araña roja o el Thrips parvispinus que, otros años, ya estarían controladas en estas fechas por la propia climatología.
“Todo esto viene influenciado por el cambio climático, y estos últimos años de forma exponencial”, sentencia para FHALMERÍA Fernando Paniagua, presidente del Colegio de Ingenieros Agrícolas de Almería (COITAAL), que, como explica, también afecta al cuaje de los frutos. “Estamos en un punto en el que las plantas no paran de crecer, pero dejan de lado las flores”, afirma, “tenemos muchísimas hectáreas de pimiento en el emparrillado y haciendo ya cueva, van como locas para arriba, lo que conlleva mucha planta, mucha hoja, pero poco cuaje, se es-
En cuanto a las plagas, “tienen condiciones muy buenas para su reproducción, sobre todo la araña roja, parvispinus y Frankliniella Occidentalis, que están haciendo un daño catastrófico”, asegura Paniagua, para además, señalar que “los ingenieros agrícolas nos vemos con las manos atadas, no tenemos herramientas eficientes suficientes para controlar estos ataques, concentrados en los cultivos de pimiento”.
“No estamos acostumbrados a esta situación en octubre”, apunta José Ángel Fernández, técnico agrícola y agricultor en la zona del Poniente almeriense, “con una humedad relativa alta y menos de 20 grados ya tendríamos controlada la araña roja”.
“Estamos rezando para que se meta el frío”, continúa, “a partir de 12,7 grados, el Thrips parvispinus reduce su velocidad de reproducción”.
Sin recursos
“La lucha biológica de hoy en día no está todavía adaptada al parvispinus”, explica el presidente de COITAAL, “cuenta con un exoesqueleto muy fuerte que

le hace resistente a la mayoría de materias activas de las que disponemos”, además de mostrar comportamientos que todavía no se comprenden del todo, como, por ejemplo, que “se defienden en grupo”.
Ante esta falta de recursos, Paniagua no duda en acusar de forma directa a la Unión Europea “que en los últimos cuatro años, Europa ha eliminado del registro a 76 materias activas”, declara. “Como profesionales no queremos volver a los productos químicos, pero, sabiendo la realidad del campo, no nos pueden quitar opciones sin dar alternativas”.
“Estamos en jaque, nos ha pillado de sorpresa”, reconoce Fernández, “pero todos los cultivos almerienses han pasado en algún momento por ahí”. “Pasó con el Spotted, el Nueva Delhi o la Tuta absoluta”, prosigue, “parecía que iba a ser inviable volver al pimiento, al calabacín o al tomate, y ahí están con más kilos que nunca. No sabemos cuándo acabará, pero la esperanza está ahí”.
Lluvias
No solo es el frío, la lluvia también parece estar esforzándose en evitar tierras almerienses. Y es que, “este es un año muy
raro”, como declara para este medio David Cutillas, colaborador de la Asociación Meteorológica del Sureste (AMETSE).
Desde octubre del año pasado, los datos son muy desiguales dependiendo del punto de la provincia, “en Los Filabres hay una lluvia acumulada de unos 500 y 600 litros, por la dana de 2024, pero en El Toyo solo 98 litros, y en zonas como Aguadulce van camino a seis meses sin que llueva más de dos o tres litros, ¿qué sobrevive con eso?”.
Esta baja humedad tampoco favorece a ciertas especies de lucha integrada, que necesitan más. “Existen sistemas de nebulización” con los que poder hacer frente a la situación, explica Paniagua, “pero no en todas las fincas se pueden implementar, ni todos pueden pagarlo”.
En cuanto a las previsiones, parecen “imposibles”, señala Cutillas, “los modelos meteorológicos no se ponen de acuerdo, si por la mañana pone que caen 30 litros, a la tarde cambia a seis”. Al cierre de esta edición, 30 de octubre, las estimaciones indican que las deseadas lluvias podrían estar al caer.

Aborda con los protagonistas del sector temas como el agua, la mano de obra, la competencia desleal y el relevo generacional
Almudena Fernández
El presidente del PP de Andalucía, Juanma Moreno, participó este lunes 27 de octubre, en el ‘Foro Agricultura, Agua y Futuro en Andalucía’, en un abarrotado Auditorio ejidense y en un acto organizado por su partido y donde se dieron cita cientos de representantes de la sociedad civil, empresas del sector y autoridades locales y provinciales.
Moreno Bonilla señaló que Andalucía es “la primera potencia agrícola de España”, con capacidad de “generar alimento para 500 millones de personas”. A este respecto, el presidente de los populares andaluces incidió en que el sector agroalimentario es líder nacional, con “una aportación de casi el 20% al valor agregado bruto” y un récord de exportaciones de 9.250 millones de euros solo en los primeros seis meses de 2025”.
Gestión hídrica
Buena parte del discurso de Moreno Bonilla se centró en la gestión hídrica y recordó los esfuerzos en esta materia de la Junta de Andalucía desde 2019 y reclamando medidas al Gobierno que abandone su “miopía ideológica”.
En este mismo contexto, el presidente del PP andaluz, quien también es copresidente del Comité de Regiones de la UE, reclamó políticas hídricas europeas que desbloqueen la compleja situación del agro en el contexto de sequía. Igualmente, volvió a pedir al Estado la ejecución de una veintena de obras de infraestructuras clave “para el presente andaluz”. En este punto, Moreno ha recordado que está insistiendo en que “los fondos europeos nos puedan servir para hacer políticas hídricas” y también en que el presupuesto de la PAC no sea el resultado de “recortes” y de una filosofía que centralice los fondos en el Estado, “porque ya conocemos cómo se reparten después las cosas aquí y al final siempre nos toca perder”.
Por otro lado, pidió intensificar el control de los puertos para evitar la competencia desleal y la


El presidente andaluz se centró en la política de gestión hídrica. /FHALMERÍA
puesta en marcha de cláusulas espejo en los productos extracomunitarios.
En definitiva, Moreno Bonilla fue el encargado de abrir el evento, a través de una mesa redonda en la que participaron personalidades como Arancha Arias, CEO de Almazara Saturnino Arias; Fernando Rubio, presidente de la Junta Central de Usuarios de Aguas del Almanzora; Lola Gómez, fundadora y gerente de Clisol Agro; Silvia Gómez, directora general de Fresón de Palos; Fulgencio Torres, presidente de las Cooperativas Agroalimentarias de Andalucía; e Isabel Santorromán, directora de Negocio de Agrobío.
En este sentido, el presidente del PP insistió en la importancia de este encuentro para “escuchar y después proponer y acertar en nuestras propuestas”.
El modelo ejidense
La elección de El Ejido como sede del evento no ha sido casual, ya que es ejemplo de modelo de Andalucía en cooperación, tecnología y aprovechamiento eficiente del agua en el ámbito agrícola. Juanma Moreno hizo hincapié en “el enorme esfuerzo y la enorme determinación” que tuvieron los agricultores hace unos 20 o 30 años “para que en circunstancias tan difíciles como las que se pro-
ducen en Almería por falta de agua hayan conseguido que esta provincia exporte más de 3.000 millones de euros y haya tenido cotas de crecimiento económico y social que otras provincias de Andalucía no han tenido”.
“Una provincia a la que nadie le ha regalado nada y que fruto de su esfuerzo, su sacrificio y su compromiso ha conseguido llegar a lo que tiene”, dijo antes de trasladar su “enhorabuena” y el “orgullo de todos los andaluces”.
De hecho, el Poniente almeriense tuvo gran protagonismo en este evento gracias a la participación de dos empresas con sede en El Ejido: Agrobío y Clisol Agro.
De un lado, Isabel Santorromán, directora de Negocio de Agrobío, confió una vez más “en la colaboración público-privada que permitió salir de la crisis del pimiento del año 2006”, un abismo al que se asoma el sector con plagas actuales como la del Trips parvispinus. Además, dijo que “se necesita más agilidad a la hora de los registros de nuevas soluciones” que ofrezcan soluciones sostenibles a los agricultores de forma más rápida.
Además, Santorromán apuntó que “la agricultura moderna se enfrenta a tres retos: plagas invasoras, cambio climático y la exigencia de los mercados para producciones más seguras. El control biológico, dentro del contexto
de lucha integrada, da soluciones sostenibles; además, aporta un ambiente más seguro y saludable dentro de los invernaderos, protegiendo a los trabajadores y consumidores”. Para lograr todo ello, la innovación es básica y lamentó que “en la industria auxiliar estamos en tierra de nadie a la hora de acceder a ayudas”.
Por otro lado, Moreno Bonilla presentó a Lola Gómez como “referente en el turismo de invernadero”, agricultora que subrayó que las fincas almerienses son “el segundo pulmón verde más grande del planeta”. La gerente de Clisol Agro puso de relevancia la gran eficiencia hídrica en los invernaderos de la provincia gracias al riego por goteo y alabó el sistema de cooperativas, a la vez que reclamó “una administración más ágil y eficaz”, frente a una política europea “muy laxa que permite que lleguen productos con competencia desleal”.
El Levante almeriense también tuvo su protagonismo con Fernando Rubio, quien se lamentó de que “hablar de planificación cuando no hay seguridad de agua, es imposible”. El presidente de Aguas del Almanzora incidió en que “hay peligro de que los pueblos se deshabiten ya que el agua es nuestra materia prima”.
De Silvia Gómez, Moreno Bonilla escuchó su reclamación para que las infraestructuras hídricas lleguen a tiempo y no pongan en jaque campañas agrícolas, como ocurrió el año pasado en la fresa; además de trabajar por la contratación en origen.
Por su parte, Fulgencio Torres, reconoció que “las cooperativas tenemos que coger músculo y dimensión; hay que innovar y aplicar nuevas tecnologías y no quedarnos fuera del mercado; siempre de la mano de las administraciones, a todos los niveles”, reclamando así que “no se legisle desde los despachos”. “Tenemos que hacer que el sector sea rentable y para eso se necesita tener agua”, apuntó el presidente de las Cooperativas Alimentarias de Andalucía. Finalmente, Arancha Arias remarcó que para que el sector crezca “es importante la innovación”.
La eurodiputada del PP pide “la implantación de Cláusulas de Salvaguarda para proteger a los productores”
Jessica Valverde
El nuevo acuerdo entre la UE y Marruecos continúa generando reacciones, una de las últimas, la del pasado 27 de octubre de la eurodiputada y presidenta de la Comisión de Pesca del Parlamento europeo Carmen Crespo, que afirmó que dicho acuerdo es lesivo para España, ya que supone “un alto riesgo para la rentabilidad del campo español” y es por esto que ha pedido la implantación de Cláusulas de Salvaguarda para proteger a los productores.
Al respecto, Crespo ha mostrado su preocupación por el incumplimiento de los contingentes y la falta de control, “esta realidad está provocando pérdidas a los productores españoles por valor del 50% de su cuota en el mercado europeo, mientras que Marruecos la ha incrementado un 70%”.
A esto se suma la denuncia de la eurodiputada del PP por la falta de adaptación de dicho acuerdo a la realidad actual de Europa tras la salida de Reino Unido del

mercado único y también lamentó que en el caso del mercado británico “el tomate español prácticamente haya desaparecido, perdiéndose el 80% de su presencia, una situación dramática”. Un retroceso que, tal y como ha señalado Carmen Crespo, no se limita únicamente al tomate,
sino que podría arrastrar a todo el sector hortofrutícola, debilitando aún más el tejido económico y social del mundo rural.
“Si España continúa retrocediendo en los controles de las importaciones, no solo pierde el agricultor, pierde Europa: pierde su autonomía alimentaria y su
Luis Saracho
En los últimos años, el Mar Menor se ha convertido en el espejo donde se reflejan los errores de la gestión ambiental en el sureste español. Lo que comenzó como un problema localizado de eutrofización ha derivado en una catástrofe ecológica: la laguna más grande de Europa sufre episodios de anoxia, mortandades masivas de peces y restricciones severas a los agricultores murcianos. Según diversos observadores, como la plataforma
S.O.S. Rural, gran parte de este desastre no procede únicamente de los nitratos agrícolas, sino del vertido continuado de aguas ur-
banas y tanques de tormenta a través de la Rambla del Albujón, que han arrastrado materia orgánica y contaminantes directamente hasta la laguna. En Almería, donde las ramblas también son el sistema natural de evacuación del agua, conviene tomar nota. La prevención empieza en la red de saneamiento, y en ese sentido las administraciones están actuando con acierto. La Junta de Andalucía acaba de licitar el nuevo colector de Níjar y Fernán Pérez, con una inversión superior a 1,2 millones de euros, para conectar los núcleos del municipio con la depuradora de El Viso y evitar vertidos sin tratar. A su vez, la Diputación Provincial ha inicia -
do en Olula del Río las obras de reparación del colector de aguas residuales que une Macael con Fines, dentro de un plan de más de diez millones de euros para restaurar infraestructuras dañadas por la DANA. Tomar ejemplo de lo ocurrido en la vecina Murcia puede ayudarnos a separar el grano de la paja y distinguir entre las medidas meramente estéticas, que buscan un titular fácil, y aquellas que, sin hacer ruido, trabajan por el futuro de nuestra agricultura. Actuaciones como la reparación y mejora de los colectores son las que realmente garantizan que el sector mantenga sus estándares de calidad y sostenibilidad.
capacidad de garantizar un modelo de producción propio, seguro y sostenible”, ha insistido.
Para Crespo, el acuerdo UEMarruecos, lejos de corregir los desequilibrios existentes, “puede llevar a profundizar más una competencia desleal que debemos frenar defendiendo la im-
plantación de medidas concretas”.
Entre esas medidas para proteger a los agricultores la eurodiputada popular ha apostado por la puesta en marcha de la Oficina Europea de Control de Importaciones; la implantación de las Cláusulas de Salvaguarda automáticas para proteger a los productores; frenar las importaciones de forma inmediata si los volúmenes de productos importados suben más de un 10% o si los precios caen más del 10% en uno o varios estados miembros; e impulsar un etiquetado europeo para poner en valor el producto que cultivan con calidad los agricultores y ganaderos.
Por último, Carmen Crespo ha pedido al Gobierno de España que refuerce los puntos de inspección fronteriza de todos los puertos con más recursos de personal, económicos y tecnologías para ejercer de verdad una vigilancia sobre las importaciones a fin de garantizar la trazabilidad, la reciprocidad y el cumplimiento de los acuerdos para evitar que el sector agrario español siga saliendo perjudicado.

El acuerdo supone un paso importante a la hora de consolidar a la ciudad como referente europeo en sostenibilidad hídrica
fhalmería
El Ayuntamiento de Roquetas de Mar, a través del Consorcio para la Gestión del Ciclo Integral del Agua del Poniente Almeriense, ha firmado este mes de octubre el contrato regulador de producción, suministro y distribución de agua regenerada con la Junta Central de Usuarios de la Masa de Agua Subterránea Campo de Dalías-Sierra de Gádor. Un acuerdo que permitirá de esta forma la utilización de agua regenerada procedente de la Estación Depuradora de Aguas Residuales (EDAR) de Roquetas de Mar, con certificación sanitaria clase AA, para el riego agrícola en más de 6.000 hectáreas gestionadas por la Comunidad de Regantes Sol y Arena, en el Poniente almeriense.
El alcalde de Roquetas de Mar y presidente del Consorcio, Gabriel Amat, ha destacado la importancia del convenio para el futuro del municipio y de toda la comarca. “Este contrato es un paso decisivo en nuestra estrategia de sostenibilidad y eficiencia en el uso del agua. Gracias a esta colaboración, conseguimos que cada gota tenga una segunda vida útil y contribuya al desarrollo

agrícola sin comprometer nuestros recursos naturales. Roquetas de Mar vuelve a situarse a la vanguardia de la gestión hídrica en España y en Europa”, celebraba el primer edil roquetero.
En definitiva, el acuerdo, firmado en la Casa Consistorial, regula así la producción y sumi-
nistro de aguas regeneradas clase AA, cumpliendo los requisitos establecidos en el Real Decreto 1085/2024 sobre reutilización del agua, e incluye una adenda económica que garantiza la sostenibilidad de las instalaciones y el mantenimiento operativo de la planta.
La Junta calcula unos 2.000 millones de euros de pérdidas
Efhalmería
l consejero de Agricultura, Pesca, Agua y Desarrollo Rural, Ramón FernándezPacheco, ha alertado recientemente de que, según las estimaciones de la Junta de Andalucía, “el sector agrario andaluz podría perder alrededor de 2.000 millones de euros en ayudas con el mo-
delo de PAC para 2028-2034 propuesto por la Comisión Europea, lo que tendría un grave reflejo en la economía de los productores”. Durante su intervención, Fernández-Pacheco ha insistido en que “la nueva PAC no es agraria ni común y, desde luego, es injusta y perjudicial para Andalucía”. “Desde Andalucía hemos pedido al Gobierno de España que exija en
El BOJA publica tres años más de Extensión de Norma en materia de calidad

La Organización Interprofesional de Frutas y Hortalizas de Andalucía (HORTYFRUTA) ha informado que el último Boletín Oficial de la Junta de Andalucía (BOJA) recoge la Extensión de Norma en materia de calidad, que será de aplicación para las tres próximas campañas hortofrutícolas.
Esta medida, aprobada por unanimidad el pasado mes de mayo por el Consejo Andaluz de Organizaciones Interprofesionales Agroalimentarias, extiende al conjunto del sector el acuerdo alcanzado por HORTYFRUTA, estableciendo la comercialización exclusiva de las categorías extra y primera de productos como pimiento, tomate, pepino, calabacín, berenjena, melón y sandía. Según la publicación del Boletín Oficial de la Junta de Andalu-
cía, todos los operadores implicados están obligados a financiar los gastos derivados de la ejecución y control del cumplimiento de la medida a través de una aportación económica obligatoria. Esta medida responde así a la necesidad de garantizar que, cuando se produce una distorsión de mercado, el sector opere bajo los mismos estándares mínimos de calidad, evitando desequilibrios que puedan perjudicar la imagen y competitividad de sus producciones. Y es que, según Juan Tomás Cano, presidente de HORTYFRUTA, “desde la Interprofesional se obra con la certeza de que las medidas adoptadas en el marco de la Extensión de Norma garantizan la calidad y sostenibilidad de las producciones hortofrutícolas ante los desafíos del mercado, brindando así un respaldo a los productores en tiempos de crisis”.
el Consejo Europeo el cambio de modelo, que bloquee este recorte del 22 por ciento del presupuesto, que diga un no rotundo a una PAC lesiva para los agricultores andaluces y que fuerce a un cambio de la PAC con su voto en contra en Europa”, ha abundado el consejero almeriense. Por ello, “desde Andalucía nos oponemos frontalmente al fondo

El consejero durante su intervención. /FHALMERÍA
único y al cambio de estructura que el nuevo marco financiero europeo establece para la PAC. Necesitamos una PAC fuerte, independiente de otros fondos, en base
a dos pilares, con la voz protagonista de las regiones y que tenga en cuenta la realidad productiva de cada zona, de Andalucía”, explicó el consejero.
Solicitan igualar el coste del metro cúbico de agua desalada con respecto al procedente de la de Carboneras
Asaja Almería, a través de su presidenta Adoración Blanque, ha presentado una solicitud ante la Secretaría General del Agua de la Junta de Andalucía para que eleve al Ministerio de Transición Ecológica una petición para que se pongan en marcha los mecanismos necesarios que permitan bonificar el coste del agua desalada procedente de la desaladora ‘Mar de Alborán’ para los regantes que la requieran, de forma que sea igual al fijado por el agua producida en la desaladora de Carboneras, y que está fijado en 0,45 euros/ m³.
La petición se basa en el carácter de “interés general” que representa esta infraestructura para garantizar el riego en la zona de influencia de la desaladora ‘Mar de Alborán’, entre la que se encuentra el campo de Níjar, en un contexto de sequía meteorológica prolongada y de sobreexplotación del acuífero del Campo de Níjar.
Para ASAJA esta compensación en el precio del uso del agua desalada busca evitar desigualdades entre agricultores por el lugar de producción del recurso hídrico y garantizar condiciones equitati-

vas de producción. “Los agricultores de Almería y Níjar necesitan el agua de la desaladora para sacar adelante su producción, y es justo que puedan hacerlo en condiciones de igualdad respecto a quienes pueden emplear agua de la de Carboneras. El Ministerio tiene en su mano el poder bonificarles el precio del agua”, señala Adoración Blanque.
Cabe recordar que la desaladora ‘Mar de Alborán’ abastece actualmente a 432 hectáreas de cultivo mediante una red de distribución de 170 kilómetros y seis balsas de acumulación con capacidad de hasta 600.000 m³.
“La desaladora es necesaria para la zona, permitiendo a 432 hectáreas el aprovechamiento óptimo de todos los recursos hídricos que se necesitan para mantener la actividad agraria. Además, contribuye a evitar una mayor sobreexplotación del acuífero del Campo de Níjar, es decir, que estamos ante una infraestructura de interés general que requiere de una medida de apoyo como la bonificación en el coste del agua para los regantes”, subraya la Presidenta de ASAJA-Almería. que confía en que la Junta de Andalucía atienda esta petición con urgencia.
“La sequía sigue acechando al Levante”: el PP urge las obras de la desaladora del Bajo Almanzora
La parlamentaria andaluza del Partido Popular de Almería, Ángeles Martínez, ha vuelto a exigir al Gobierno de España “urgencia” en las obras de la desaladora del Bajo Almanzora porque según ha explicado “la sequía sigue acechando al Levante almeriense
donde el embalse de Cuevas se encuentra actualmente a un 6,27% de su capacidad”.
La parlamentaria popular señala que la situación de los agricultores es desesperada porque no solo no se ejecuta la reparación de la desaladora del Bajo Almanzora I, sino que no se sabe nada de las obras de la desaladora del Bajo Almanzora II y encima, el Go-
Con motivo del Día Internacional de la Mujer Rural, Almería capital acogía la II Convención Regional de Mujeres Rurales, organizada por la Asociación de Emprendedoras Rurales de Andalucía (AERAN).
Tal y como señalaba la presidenta de AERAN, Adoración Blanque, al inicio del evento, “somos lo que comemos, por eso hoy mujer, salud y dieta mediterránea se aúnan para visibilizar la aportación que tradicionalmente han tenido las mujeres del mundo rural en la trasmisión de nuestras recetas tradicionales, basadas en la tan valorada dieta mediterránea, usando productos frescos, y de proximidad. Han jugado y juegan un rol fundamental en la promoción de una alimentación saludable, y creemos necesario darle la importancia que merece”. Por otro lado recordó el trabajo que la asociación está llevando a cabo para dar formación, asesoramiento y acompañamiento para que las mujeres que lo deseen puedan llevar a cabo su proyecto empresarial y profesional, de hecho más de 700 mujeres han participado en los diferentes programas llevados a cabo por la asociación en el último año.
Además se contó con la presencia de la Viceconsejera de Agricultura de la Junta de Andalucía, Consolación Vera, que valoró la realización de este tipo de eventos como una vía más de trasmi-
sión del papel de las mujeres rurales y el valor de los productos producidos en la provincia de Almería, “y eso es gracias al esfuerzo que cada día ponen los hombres y mujeres del sector agrario”. Por su parte, el Delegado Territorial de Salud y Familia, Juan de la Cruz Belmonte, destacó el papel de la mujeres como principales promotoras de la dieta mediterránea.
La berenjena, protagonista Dentro del bloque de ponencias, en primer lugar se abordaron diferentes estudios e investigaciones sobre cómo potenciar la introducción de la berenjena en la cocina mediante diferentes tipos de elaboración, para ello se escogió a un grupo de mujeres para realizar catas para contribuir a las investigaciones que en esta materia está desarrollando la Universidad de Alicante.
Cerraba la convención del secretario de organización de ASAJA Nacional, Juan José Álvarez, quien quiso además de apuntar el valor de lo producido en España en materia de seguridad alimentaria y calidad, la necesidad de clarificar y llamar a las cosas por su nombre para que consumidor sepa bien cómo se produce y dónde. Pero además, también criticó el anuncio de una nueva subida de cuotas para los autónomos, señalando que “los costes se han disparado y no podemos permitirnos que nuestro sector pierda más explotaciones”.
bierno no duda en recortar el agua del trasvase Tajo-Segura, un cóctel explosivo que va a suponer un rejón de muerte para la agricultura del Levante y del Almanzora. Por otra parte, la parlamentaria popular se ha referido a la Junta de Andalucía y ha señalado que desde la consejería que dirige el almeriense Ramón Fernández-Pacheco, no levantan el pie

La parlamentaria Ángeles Martínez.
del acelerador y continúan haciendo obras hidráulicas para reforzar y seguir aumentando la
capacidad de acumular agua en Almería y toda la comunidad autónoma.
La Unidad Aceleradora de Proyectos de la Junta agilizará los trámites para poner en marcha esta iniciativa. El proyecto se encuentra alineado con el ‘I Plan Estratégico para las Frutas y Hortalizas de Invernadero de Andalucía. Horizonte 2030’
El Consejo de Gobierno ha tomado razón de la asignación a la Unidad Aceleradora de Proyectos (UAP) del proyecto del Parque Biotecnológico Agrobío para el Control Biológico y la Biopolinización en La Mojonera (Almería), que será el más grande de Europa. La Junta de Andalucía considera la iniciativa estratégica al contribuir a mejorar la competitividad y sostenibilidad de los invernaderos hortofrutícolas, impulsar la investigación, innovación y transferencia de conocimientos y elevar el nivel formativo y las competencias empresariales de los agentes del sector agroindustrial.
El proyecto se encuentra alineado con el ‘I Plan Estratégico para las Frutas y Hortalizas de Invernadero de Andalucía. Horizonte 2030’ de la Junta de Andalucía y, en el ámbito municipal, se prevé que fortalezca el liderazgo en innovación agraria en el municipio de La Mojonera. La Junta de Andalucía considera que promoverá la sostenibilidad y modernización del sector andaluz e impulsará a Almería como líder en biotecnología agrícola, atrayendo nuevas inversiones y fortaleciendo la cadena de suministro local.
Agrobío promueve esta iniciativa por la que se ampliará su biofábrica actual para agrupar en un único espacio las instalaciones de producción, comercialización, I+D, innovación, asesoramiento y formación de organismos de control biológico destinados a lucha integrada de plagas. Entre otras líneas de actuación, se criarán abejorros para la polinización natural de los cultivos y se trabajará en diversas cuestiones ligadas a la regeneración de suelo y el control conservativo. Agrobío cuenta ya con décadas de experiencia tanto en la producción de insectos beneficiosos para el control biológicos de plagas de cultivos como en la cría de abejorros destinados a polinizar hortícolas y frutales, plantas de parques y jardines o

ubicadas en viveros y zonas forestales.
En términos de empleo, se calcula que la construcción del Parque Biotecnológico Agrobío para el Control Biológico y la Biopolinización generará 50 puestos de trabajo; y que la explotación de las instalaciones supondrá la creación de otros 250 empleos en cinco años. En el ámbito económico, la Junta de Andalucía estima que la facturación media anual alcanzará los 60 millones de euros, con un importante peso del mercado internacional (más del 60%). La asignación a la UAP conlleva la agilización de los pro-
cedimientos ligados a la Junta de Andalucía, ya que la iniciativa se gestiona por la vía de tramitación preferente y urgente.
Medalla de la Agricultura
El Pabellón de Balanegra acogerá el día 16 de noviembre un acto en el que se premiará y ensalzará el trabajo de las personas, instituciones y entidades que con su entrega y talento contribuyen a la prosperidad de todos los municipios de Almería.
Son cinco categorías en las que se van a entregar estas Medallas de la Provincia, siendo una de estas la Medalla de la Agricultura,
que será entregada a Agrobío por ser una empresa de referencia internacional especializada en la producción y comercialización de fauna auxiliar para el control biológico de plagas y colmenas de abejorros para la polinización natural en cultivos agrícolas, siendo su actividad crucial para impulsar una agricultura sostenible, con residuo cero y que garantiza la seguridad agroalimentaria. Con su trabajo, destinado a la cría de insectos beneficiosos y abejorros en su biofábrica, replicando condiciones naturales para asegurar la máxima calidad y vigor de los organismo, siendo esta labor fun-
damental para transformar el modelo agrícola almeriense.
La empresa se distingue por su fuerte y constante apuesta por la Investigación, el Desarrollo y la Innovación (I+D+i), que le permite desarrollar nuevas herramientas y protocolos para un control biológico más eficaz y temprano. Es una de las principales productoras mundiales de su sector. Exporta el talento y nuestro modelo agrícola a 35 países convirtiéndose en un potente referente de la excelencia e innovación que constituye el agro almeriense en el panorama internacional.


Tomate de Primavera
Rijk Zwaan asegura el cultivo de tomate con variedades que destacan por sus resistencias, sabor, calibre, color y conservación
Elena Sánchez
El tomate es uno de los productos estrella de la provincia de Almería y son más de 8.000 hectáreas las que hay de tomate en el campo almeriense hasta la campaña 2024-2025. Esto supone la necesidad de ofrecer un amplio abanico de soluciones para el agricultor en todas las tipologías y, además, con las resistencias necesarias para hacer frente a las adversidades.
La obtentora de semillas holandesa Rijk Zwaan es un claro ejemplo de la evolución que se está viendo en tomate, ya
El tomate pera es una de las tipologías más demandadas por los productores en la provincia y solamente esto ya es un motivo para que desde Rijk Zwaan no cesen su empeño de aportar su ayuda con las herramientas más adecuadas.
que en los últimos años ha conseguido formar un portfolio completo de variedades para cada una de las tipologías y ciclos de producción que están dando los mejores resultados tanto en número de kilos como en calidad, sabor, color, postcosecha, tamaño o consistencia. Además, cabe destacar dentro del segmento de tomate de Rijk Zwaan, su nuevo concepto Rugose Defense que ofrece materiales con alta resistencia al virus del rugoso.
En este sentido, para el ciclo primavera-verano, Rijk Zwaan propone grandes soluciones adaptadas a las necesidades del agricultor y para todas las zonas.


En este sentido, para primavera-verano se hace hincapié en dos variedades:
pera
exportación
Esta nueva variedad de Rijk Zwaan destaca, principalmente, por encontrarse dentro del concepto Rugose Defense y por ser un tomate ideal para exportación. Esta propuesta de la firma holandesa en la tipología pera se
caracteriza por su calidad de piel y porque mantiene calibre y forma durante todo el ciclo. Además, también es muy recomendable por su cierre peduncular pequeño, buena vida comercial y color rojo intenso.


Otra de las novedades en tomate pera de Rijk Zwaan es la variedad Barmet RZ, un material que goza de gran calibre, elevada producción y muy buena vida comercial. Barmet RZ está recomendado
para ciclo largo de otoño-invierno o ciclo corto de primavera, ya que, al igual que Alginet RZ, es una variedad que mantiene calibre y forma hasta el final del ciclo.
La tipología de tomate cherry está en auge en la provincia almeriense y su calidad, sabor, tamaño y color superior están permitiendo que el mercado valore este producto como uno de los más importantes para su comercialización.
En este sentido, Rijk Zwaan cuenta con una importante oferta en cada tipología de cherry que está dejando grandes sensaciones, sobre todo, por su excelente sabor.
Dentro del segmento de cherry suelto, Guindyta RZ se presenta como una variedad que se caracteriza por sus frutos de buen color y excelente sabor, sin tendencia al rajado. Además, este material de Rijk Zwaan está indicado para recolección en suelto y sus frutos tienen un calibre muy homogéneo durante todo el ciclo de entre 25 y 30 mm. Guindyta RZ, que se encuentra dentro del concepto Rugose Defense, está indicado para trasplantes de primavera-verano.
Este cherry redondo, para recolección en suelto, cuenta con una planta vigorosa y con frutos de calibre promedio entre 27 y 32 mm, que destacan por un gran sabor llegando a los 8,5 grados brix. Además, Coralyta RZ está recomendado tanto para ciclos de primavera-verano como de otoño-invierno y goza de una larga vida comercial, ideal para exportación.



En la tipología de cherry rama, la obtentora de semillas holandesa hace especial hincapié en Talavante RZ, un material que también pertenece a la familia Rugose Defense por su alta resistencia a rugoso y que tiene una buena vida comercial. Además, como buen cherry, también destaca por su excelente color de fruto, así como por sus altos grados brix aportando un sabor ideal.

Abrametto RZ es un cherry pera muy completo ya que asegura al agricultor excelentes cuajes con bajas y altas temperaturas, postcosecha, calibre mantenido todo el ciclo, color y resistencias, al estar dentro del concepto Rugose Defense. Además, esta variedad también se caracteriza porque presenta una planta muy sana, de raíz fuerte y que aporta frutos de calidad y elevada consistencia.




Aunque Rijk Zwaan sigue avanzando hacia variedades que cierren el círculo y sean totalmente completas tanto en resistencias como en características generales, dentro de la tipología de tomate beef, la firma holandesa parte con dos referencias que se mantienen en el mercado y que están dando muy buenos resultados como son Alvalade RZ y Errasty RZ, materiales que destacan por gozar de tamaño adecuado, buen color y sabor y por ser frutos consistentes tanto en planta como en la postcosecha. Alvalade RZ está recomendado para temprano (noviembre-diciembre), mientras que Errasty RZ es más para enero, febrero y marzo. Sin embargo, Rijk Zwaan ha querido ir más allá y apostar por novedades que también están ayudando a los agricultores a lograr sus objetivos de campaña.


Dentro de la tipología de tomate beef, Arystema RZ es una de las tres novedades que presenta la firma holandesa para primavera temprana. Según explica Manuel Hernández, especialista de tomate de Rijk Zwaan, “esta variedad goza de una planta compacta, de calibre G-GG y sin tendencia al blotching”. Además,
Arystema RZ se encuentra dentro del concepto Rugose Defense, por lo que ofrece una alta resistencia al virus del rugoso, que sumado a su elevada producción, y frutos de gran calidad, color y brillo hacen de este material uno de los más indicados para recolectar tanto en pintón como en rojo.


La segunda de las novedades de tomate beef que forma parte, también, del concepto Rugose Defense, es Abeyan RZ, un material indicado para enero, febrero y marzo que tiene varias características especiales
como frutos de buen calibre que oscilan entre los 200 y los 220 gramos, de muy buena calidad y con una planta vigorosa y altamente productiva.

La tercera de las nuevas incorporaciones al portfolio de Rijk Zwaan en tipología beef es Theracan RZ (74-BF2710 RZ), una variedad muy productiva con frutos de calibre GG de muy buena calidad ideales para el mercado. Theracan RZ, indicado para


recolección en suelto, destaca también por ser una planta compacta y precoz, que está respondiendo con garantías a las demandas tanto de agricultores como de supermercados.


Intermedio suelto larga vida

Dentro de la tipología de tomate intermedio suelto larga vida, Rijk Zwaan hace especial hincapié en Aluwa RZ, un material que también forma parte de la familia Rugose Defense y que destaca por su buen comportamiento tanto en invernadero de
plástico como de malla. Según Manuel Hernández, especialista de tomate de Rijk Zwaan, Aluwa RZ es ideal por sus frutos de calibre G-GG de 160-200 gramos, así como por su buen color, calidad y conservación durante todo el ciclo.

Como pasa con el tomate pera, que Rijk Zwaan parte en su portfolio de variedades más que consolidadas y contrastadas, en la tipología de tomate rama, la obtentora de semillas holandesa también cuenta con materiales referentes a partir de los cuales se han propuesto novedades.
Pontal RZ y Realsol RZ se han convertido en referencia para los agricultores de rama en la provincia, que ven en estos materiales dos opciones seguras para conseguir frutos de primera y que tienen una gran respuesta en el mercado gracias a su elevada calidad y postcosecha.
En el caso de Pontal RZ, se trata de un tomate de gran calibre y excelente firmeza indicado para recolectar en ramo y cuenta con una planta equilibrada de entrenudo
medio-corto. Por otro lado, en el caso de Realsol RZ se caracteriza por su planta vigorosa y equilibrada, así como por su precocidad a la hora de coger fruto. Como explica Manuel Hernández, especialista de tomate de Rijk Zwaan, Realsol RZ goza de unos ramos que están bien formados, frutos de color rojo intenso, duros, uniformes, de calibre M-G, sin tendencia al rajado y de excelente calidad.
Sin embargo, para seguir avanzando en nuevas soluciones que se adapten aún más si cabe a las necesidades del agricultor de hoy en día y a las adversidades del campo que se presentan campaña tras campaña, la firma holandesa presenta nuevas variedades que vienen a fortalecer la oferta de tomate rama, ya que también incorporan la novedosa alta resistencia al rugoso.

En el caso de la novedad Ricosol RZ, esta es una variedad que está recomendada para ciclos de primavera-verano con una planta vigorosa y equilibrada. Sus ramos son uniformes con frutos que tiene un calibre promedio de 130 gramos, además de que se caracterizan por su color rojo intenso, sin tendencia al rajado, buena firmeza y larga vida comercial. Su alta resistencia
al rugoso permite minimizar los daños en el cultivo, además de que, como no podía ser de otra manera, limita la propagación, siendo un perfecto escudo contra este virus que tanto daño está haciendo en las plantaciones de tomate de la provincia de Almería.



Perteneciente también al concepto Rugose Defense por su alta resistencia al rugoso, Fierasol RZ está siendo una de las novedades en tomate rama con más presencia en el campo almeriense gracias a que es una variedad ideal para aquellos agricultores que necesiten obtener más productividad en menos espacio de tiempo, es decir, es mucho más precoz que otros materiales del mercado. Además, como
aseguran desde Rijk Zwaan, Fierasol RZ se caracteriza por su planta compacta con ramos largos para ciclos cortos de primavera-verano y un otoño temprano. Los frutos de esta variedad destacan por su buena firmeza, excelente color y forma, con ramos que echan unos siete frutos cada uno. Por otro lado, Fierasol RZ goza de una buena vida comercial por su gran consistencia




Desde Rijk Zwaan aseguran que combinar la variedad y el portainjerto con alta resistencia es la mejor defensa para una campaña libre de virus
Elena Sánchez
Empezar con buen pie una cosecha es fundamental y sobre todo cuando en las últimas campañas, los virus y plagas están siendo más protagonistas de lo deseado. En el caso del tomate, el virus del rugoso continúa estando presente en los invernaderos y resulta necesario tener una buena planificación y elegir bien no solamente la variedad con la que se va a trabajar, sino también el portainjerto.
Rijk Zwaan ha lanzado tres nuevos ‘portas’ con alta resistencia al rugoso que, además, ofrecen vigor, seguridad sanitaria y adaptabilidad, reforzando la protección desde la raíz y sumando garantías tanto en el cultivo como en el semillero. Y es que, como indican desde la casa de semillas, combinar la variedad y el portainjerto con alta resistencia es, hoy, la mejor defensa para una campaña libre de rugoso.

Así, las tres novedades de Rijk Zwaan ya disponibles son:
Callum RZ
Un porta de vigor medio-alto y muy equilibrado con resistencia alta a rugoso, que está recomendado para todos los ciclos de cultivo. Además, como explican desde la firma holandesa, Callum RZ es adecuado para variedades que no necesitan un aporte extra de vigor.

Brantley RZ
Es un portainjerto de vigor alto con gran poder generativo ideal para ciclos largos y con alta resistencia al virus del rugoso. Además, destaca porque tiene un excelente comportamiento en invierno y con baja luminosidad, así como también se trata de un material que favorece una mayor floración, cuajada y calibre de frutos.

Tirian RZ
Es el ‘porta’ de alta resistencia al rugoso que tiene un vigor alto y es ligeramente vegetativo. Como explican desde Rijk Zwaan, Tirian RZ está recomendado en condiciones de cultivo estresantes, así como también es ideal porque aporta fuerza y cobertura foliar en condiciones extremas.

























Sapia es la nueva aplicación de Bayer para facilitar la comunicación y el trabajo entre técnicos y agricultores.












Piel fina y pulpa jugosa, equilibrio entre acidez y dulzor, además de umami en cada bocado caracterizan a esta innovación
Los conocidos chefs Hermanos Torres han sido, una vez más, los maestros de ceremonias en el stand de Sakata Seed Ibérica para mostrar las novedades de su catálogo en el gran escenario que supone la celebración de Fruit Attracion.
En esta ocasión, el protagonista ha sido Japi, el tomate que llega “para hacer feliz al consumidor”. El gerente de Sakata Seed Ibérica, Francisco Morales, subrayó que “Japi no es solo un tomate, es una experiencia sensorial única. Queremos revolucionar el mercado ofreciendo un producto que cumple con la demanda más importante del consumidor: el sabor”. De hecho, esta innovación se define por su piel fina y pulpa jugosa además de por su característico crunch que aporta “sabor umami en cada bocado, proveniente de su corazón verde rico en ácido glutámico”. Estas características aportan a esta novedad de Sakata el equilibrio perfecto entre dulzor, acidez y firmeza posicionando a Japi “como un nuevo referente en el segmento gourmet”.
Más novedades
En cualquier caso, más allá de la presentación de Japi, el stand de Sakata se convirtió desde el pabellón 9 de IFEMA en un verdadero escaparate de innovación, mostrando su amplia oferta de cultivos adaptados a las necesidades

del mercado. Sakata llevó hasta Madrid todas las nuevas variedades de brócoli, melón, calabaza butternut, pimiento, cebolla, pepino y calabacín, así como el nuevo Saiko Star, un tomate baby plum rojo que destaca por su productividad, calidad constante, vida útil y sabor, consolidándose como una “estrella” para productores y consumidores.
Desde la multinacional de semillas confirmaron que su apuesta anual por acudir hasta Fruit Attraction “viene a reafirmar el compromiso con la innovación y la proyección internacional” de sus distintas variedades hortícolas.

durante la presentación de su nuevo tomate gourmet.

Agrobío ofreció una experiencia inmersiva con su stand, donde se reproducía un ecosistema con soluciones biológicas que cobran vida. /A. FERNÁNDEZ

Parte de la Junta Rectora de Vicasol posando en el espacio dedicado al tomate como producto estrella de la feria, en el acto de presentación que tuvo lugar el primer día. /A. FERNÁNDEZ



Ecoinver llevó una importante delegación a la feria del sector, donde aprovecharon para presentar su nueva imagen corporativa y página web. /FHALMERÍA

Algunos de los concejales de Vox El Ejido y el portavoz adjunto de VOX en el Parlamento de Andalucía acudieron hasta Madrid para apoyar a las empresas de la localidad y provincia. /A. F. V.

La compañía ha anunciado en la feria internacional que va a comercializar dos nuevas referencias: la piña y el mango
Antonio Alarcón, CEO de Bollo Natural Fruit, presentó en la última Fruit Attraction las conclusiones de un estudio reciente sobre tendencias actuales que están marcando la compra y el consumo de fruta.
Entre estas tendencias, se encuentra el creciente protagonismo de los formatos de cuarta gama (fruta troceada y envasada, lista para consumir), con la que la compañía entra en un nuevo segmento para potenciar su apuesta por la innovación y responder a factores cada vez más relevantes en el consumo de fruta: la conveniencia y la facilidad de consumo.
La compañía cuenta, de momento con formatos de cuarta gama de melón, sandía, naranja, granada, mango y también calabaza, que son comercializados bajo sus dos marcas de referencia en el lineal: Bollo y Bruñó. Además, esta propuesta contempla diferentes presentaciones para el consumidor final (como monodosis, bandejas y mitades), pero también gran formato para hostelería y colectividades. Alarcón recordó que esta nueva línea de trabajo inició su andadura en marzo de este año, cuando el grupo integró en su estructura a Cortijo Cuevas, empresa granadina con una amplia experiencia en el procesado de frutas.

El CEO de Bollo Natural Fruit también anunció que su portfolio de frutas se vuelve más extenso, un movimiento con el que refuerza su vocación multifruta y su capacidad de ofrecer una cesta más amplia a lo largo de los doce meses del año. En concreto, la compañía comienza a comercializar dos nuevas referencias de corte tropical: la piña y el mango. Finalmente, Antonio Alarcón se refirió a la nueva imagen de marca Bollo, presentada oficial-
mente en Fruit Attraction, y con la que pretenden reforzar el carácter Premium de la marca, asociado a calidad y sabor, y hacerla más versátil para diferentes aplicaciones. Uno de los puntos más destacables de este cambio de identidad visual es que el icono de las monedas, tan característico de la etiqueta del melón Bollo, se traslada al visual de todo el conjunto de la marca. “Un elemento icónico que, además, se ha simplificado y actualizado”, apuntó.


Haifa dio a conocer sus productos y presentó sus últimas novedades, tanto a nivel de nutrición vegetal como de herramientas tecnológicas para la gestión del
/

Equipo de Nature Choice, quien ofrece productos hortofrutícolas de calidad para exportación a toda Europa como tomates, pepinos y pimientos de Almería. / A. FERNÁNDEZ

Grupo Armando Álvarez es en la actualidad el mayor transformador español de films plásticos de polietileno y no podía perderse esta nueva edición de la feria. / A. FERNÁNDEZ



La primera empresa hortofrutícola del Mediterráneo ofreció una rueda de prensa en Fruit Attraction para recordar sus inicios y exponer sus apuestas para los próximos años
Elena Sánchez
Anecoop está de celebración y es que cumple 50 años en el sector y, para hacer balance, Fruit Attraction fue el lugar escogido para hablar ante los medios y hacer no solo un repaso a toda su historia, sino también para exponer cuáles son los objetivos marcados de cara al futuro y cómo hacerlos posibles.
Anecoop nació en 1975 cuando 31 cooperativas citrícolas decidieron unificar su volumen de producción para abordar en mejores condiciones comerciales los mercados del Este de Europa. En la actualidad, son 61 entidades socias y representa a más de 20.000 agricultores que cultivan más de 61.000 hectáreas repartidas por toda la geografía española. En cuanto a su oferta, “ofrecemos una amplia gama de productos que incluye cítricos, frutas de temporada, frutas exóticas, hortalizas, zumos, conservas vegetales, flores y productos de IV Gama, así como una división de vinos”, como explicó el director general de Anecoop, Joan Mir.
Hitos que han marcado la historia de Anecoop Durante la rueda de prensa, se repasaron algunos de los hitos que han marcado la historia de Anecoop, destacando por encima de todo el papel fundamental de las personas que la han sostenido e impulsado a lo largo de cinco décadas. Otro de los momentos clave de la organización fue el nacimiento de su red comercial internacional con la puesta en marcha de primera filial en Francia en 1979; el lanzamiento de productos tan emblemáticos como la sandía sin pepitas Bouquet (1992) y el kaki Persimon (1997); la elaboración en esa misma década del reglamento naturane de producción integrada; el lanzamiento de campañas de comunicación para poner en valor el medio rural y

la actividad agrícola, como Raciones de Vida para el Campo (2020); su afán por ir más allá en el ámbito de la gestión sostenible, que arrancó en 2021 con su adhesión al Pacto Mundial de las Naciones Unidas y la presentación en 2023 del Observatorio de Sostenibilidad de Anecoop.
Este último “permite a nuestros socios medir de forma precisa su impacto, adaptarse a la normativa y tomar mejores decisiones en esta materia, mejorando la eficiencia, la competitividad y el valor social y ambiental del sector. De hecho, en la actualidad son 25 las entidades sociales que se han sumado a esta iniciativa”, afirmó Joan Mir.
Desde hace 25 años, Anecoop promueve avanzar en el que es uno de sus objetivos fundacionales: la formalización de procesos de integración e intercooperación entre sus socios. Según el presidente de Anecoop, Alejandro Monzón, “aspiramos a consolidar un ecosistema de entidades asociadas más compacto en número, pero más robusto y cohesionado”.
Según indicó Joan Mir durante la rueda de prensa, las directrices futuras “comprenden diversos ámbitos: la adaptación a los avances en las nuevas tecnologías, al cambio climático y a los

nuevos marcos normativos; la lucha contra las plagas, el fomento del relevo generacional que tanto nos preocupa y la puesta en valor de la producción agrícola frente al consumidor. Avanzamos también en la construcción de valor diferencial a través de la comunicación. Además, para adaptar nuestra gestión a los cambios del entorno y los mercados, hemos comenzado a trabajar con un nuevo modelo organizativo dentro de nuestro departamento comercial”.
Atraer jóvenes al campo
Por su parte, el presidente de Anecoop, Alejandro Monzón, ha querido destacar que una de las principales líneas de trabajo se centra en “avanzar en soluciones reales para atraer a los jóvenes al campo, porque sin relevo generacional, la agricultura tal y como la conocemos dejará de existir.
Anecoop celebrará este 50 Aniversario a lo largo de todo el ejercicio 2025-2026, con el reto de transformar todos estos desafíos en oportunidades para seguir avanzando en competitividad y posicionamiento internacional, mejorando la rentabilidad de sus agricultores, que según Joan Mir “son la razón de ser de Anecoop, una empresa de personas para personas”.




Han presentado sus soluciones para hortícolas, cítricos, viñedos o frutales
Almudena Fernández
La empresa Koppert ha tenido una apretada agenda en la última edición de Fruit Attraction con muchas reuniones con clientes pero, además, con distintos eventos tanto dentro como fuera de IFEMA.
Así, desde el pabellón 9 defendieron la efectividad de productos como Limonica, el ácaro depredador de Koppert que lidera el control biológico de trips y mosca blanca en invernadero; o Veni Biocuprum (cobre cuya formulación es 100% natural) y Cerasulfur (un anti-oídio líquido a base de azufre de origen biológico) para el control de enfermedades en cítricos y viñedo; además de Swirski UltiMite o Thripex Plus, como ácaros depredadores para plagas en otros cultivos como los frutos rojos. Igualmente, en la noche del martes 30, se celebró Koppert Attraction donde ponentes internacionales ayudaron a comprender los retos y oportunidades para la


agricultura europea, cuyo futuro y competitividad dependerán del control biológico.
Además, Koppert ha celebrado la II edición de los Premios Musa, un reconocimiento que distingue a las empresas que marcan el camino hacia una agricultura más sostenible gracias al uso del control biológico en el cultivo de platanera. En esta edición, las galardonadas han sido Amalur Isleña y Conagrican-Grupo FSM.








BASF presentó sus novedades en melón, sandía y tomate, además de sus soluciones de protección de cultivo con base biológica
Almudena Fernández
BASF ha llegado a Madrid para demostrar que es una compañía conectada con todos los eslabones de la cadena, con la premisa clara de seguir colaborando en la creación de valor en la industria hortofrutícola. Para afianzar este mensaje la empresa tuvo un encuentro con medios especializados en el que trasladaron novedades en distintos segmentos.
De un lado, Ester Serrano, Crop lead South Europe Tomato Fresh de BASF | Nunhems, apostilló que la búsqueda de variedades con resistencia al virus rugoso del tomate “sigue siendo el principal reto del sector”, pero desde la obtentora no descuidan otros aspectos recordando que “a veces se puede tener todo”. Así, Serrano se refirió a variedades referencia del catálogo de BASF | Nunhems como Azovian, Cabosur* y Caboluna*, a las que recientemente se ha sumado Beires*. Además, recordó que la empresa ha sido pionera en introducir en el mercado Palmeo*, el primer tomate suelto con resistencia al ToBRFV, además de a Fulvia.
En el mercado de tomate cherry, Ester Serrano recordó referencias en redondo como Daivion*,

que aporta grandes ventajas como “su entrenudo corto, favoreciendo la menor necesidad de mano de obra”, aunque remarcó la fuerte apuesta por cherry pera para invernaderos de media y alta tecnología con propuestas como Vitalion, Marvelion* y Purion*. A todas estas propuestas se sumarán novedades de la gama Intense®, tanto para mercado nacional como de Marruecos; además de una campaña marcada por la promoción de sus portainjertos con resistencia Dreampower y la novedad MassPower*
Por otro lado, Juan Pedro Pérez, Regional Crop Lead de melón y sandía de BASF, se refirió a
“The Melonution como el nuevo movimiento estratégico” de la compañía sustentado en cuatro pilares. Por un lado, combinan la producción y calidad con necesidades agronómicas dando lugar a su línea de ‘superplantas’ en melón piel de sapo con variedades como Izalco o la novedad Aralco; además de los cantaloup Thebes o Delphes o las novedades en sandía JB408º o Belamodel. En el segundo pilar de confianza, BASF | Nunhems aboga por profundizar en proyectos como Galkia®, en melón, o Fashion®, en sandía. El tercer pilar de innovación aglutina propuestas como los melones Dino, de carne blanca, o sus san-

días unipersonales como la reconocida Takemi*. Finalmente, el pilar de versalitidad incluye variedades de sandía con ‘Dual purpose’ tanto para consumo en fresco como mínimamente procesado.
BioSolutions
En el encuentro con medios, y gracias a la presencia de todas las divisiones de negocio de BASF en Madrid, también fue posible conocer la amplia gama de productos biológicos de alto rendimiento de la empresa para proteger a los cultivos de forma natural. Natalia Mate, de Comunicación de BASF, se refirió a soluciones biofungicidas, bioinsecticidas y a base de fe-
BASF | Nunhems y la Cooperativa Agrícola San Isidro (CASI) dieron un paso más en Fruit Attraction en una colaboración iniciada hace años y que les ha llevado a impulsar el mercado del tomate rosa en el continente europeo. De este modo, CASI comercializa en exclusiva tomates redondos lisos en distintos calibres y también peras rosa de la casa de semillas; un porfolio que ha aumentado en esta campaña 2025/
26,con el primer asurcado rosa que cuenta con la resistencia al virus del rugoso (ToBRFV).
La presentación de este tomate se celebró por todo lo alto el 8 de octubre en el stand de CASI con la presencia de Miguel Espinosa, Area Sales Manager de BASF en Almería; José Antonio Furió, Senior Sales Specialist de tomate de BASF; Juan Jesús Lara, director general de CASI; y Antonio Bretones, presidente de CASI.
“Fruto del trabajo conjunto con CASI, hemos logrado crecer en este mercado y abrirnos a

rormonas como Serifel®, Velifer® o Essenciel®
Finalmente, Antonella Pizzolante y Jordi Simon explicaron cómo los biopolimeros compostables y biodegradables de BASF pueden aportar plásticos para acolchado más sostenibles (que se pueden dejar en el suelo sin necesidad de retirar) o tutores y clips también elaborados con material compostable, desarrollados por la empresa en los Países Bajos y que, consideran, tienen mucho potencial en la agricultura del sudeste español en las siguientes campañas.
*APC concedido y en proceso de solicitud para la inclusión en el EC Common Catalogue of Vegetable Varieties.
otros, cubriendo a partir de ahora la demanda al alza de tomate asurcado rosa”, dijo Miguel Espinosa. Para CASI, el acuerdo en exclusividad que mantiene con la casa de semillas le ha permitido ofrecer a sus agricultores un producto “diferenciado, innovador y competitivo”, detalló su director, Juan Jesús Lara.
Con esta nueva variedad, BASF | Nunhems y CASI ofrecen un tomate que combina la seguridad agronómica de las resistencias al virus del rugoso y virus de la cuchara (TYLCV), con una buena producción y calidad organoléptica. Esta nueva variedad es de calibre G-GG, con alta productividad para el agricultor y buena vida útil para el comercializador y el propio consumidor.






un














y
y






UNIQ, el sello de calidad para envases agrícolas de cartón ondulado, hizo un balance muy positivo de su pase por Fruit Attraction en plena celebración del 10º Aniversario./FHALMERÍA




Premio Conexión con el Sector para Fruit Attraction, como plataforma clave de encuentro, visibilidad y dinamización. /E. SÁNCHEZ


El tomate Adora, de HM.Clause también fue reconocido en este espacio. /E. S. G.

El Premio Trayectoria fue, entre otros, para José Hernández, presidente de Grupo Hortofrutícola Paloma. /E. S. G.


BASF|Nunhems obtuvo premio por su aportación al sector obtentor de semillas. /E. S. G.

Ruiz, de Enza Zaden, recogió el premio por mejora genética. /E. S. G.

La Cooperativa CASI también recogió el Premio Producción y Comercialización. El encargado de subir fue su presidente Antonio




La firma holandesa presentó sus novedades orientadas a las nuevas generaciones
Rijk Zwaan volvió un año más a Fruit Attraction y esta vez lo hizo con un enfoque constante en la innovación, presentando sus últimas novedades orientadas a las tendencias de las nuevas generaciones de consumidores, desarrollando nuevos formatos, mejoras de sabor, así como productos que reducen el desperdicio alimentario y promueven una producción más sostenible. Así, la firma holandesa presentó los productos estrella que conquistan a chefs y consumidores como la sandía amarilla Tropical Honey, la sandía naranja Orange Sunglow, la Lechuga Snack® y los pimientos Tatayoyo® y Sweet Palermo®. Asismimo, en un espacio singular con soportes digitales, Rijk Zwaan presentó Teenleaf™, un concepto innovador de variedades de hoja, adaptadas a trasplantes a alta densidad (+30 plantas/m) y

diseñadas para la recolección mecanizada en la industria de IV
Gama o sus snacks sabrosos y sostenibles que reducen el desperdicio como los más que conocidos Mycubies®, la marca de pepino snack, que propone una nueva forma de hidratarse: “snackeando”.
Un producto saludable y refrescante que acompaña al consumidor en cualquier momento del día.
Finalmente, cabe destacar que Rijk Zwaan continúa avanzando
en el desarrollo de variedades de tomate con alta resistencia al virus del rugoso (ToBRFV) en todas las tipologías y que se pudieron conocer en la feria. De hecho, con el programa Tomeet, Rijk Zwaan genera valor a toda la cadena de suministro, analizando las tendencias de cultivo en las diferentes campañas, con visitas personalizadas en el CED de El Ejido (Centros de Experimentación y Desarrollo) de RZ.









Los transposones, detectados por investigadores de la UCO, han convertido a este hongo en uno de los más letales
Francisco Lirola
Investigadores de la Universidad de Córdoba (UCO) han descubierto qué es lo que ha convertido al Fusarium en una de las enfermedades fúngicas más letales para los cultivos a lo largo y ancho de este mundo.
Son los transposones, unos fragmentos de ADN que tienen la capacidad de moverse y reinsertarse en diferentes zonas del genoma. Por eso también se les conoce como genes ‘saltarines’.
“Cuando empezamos el estudio no se sabía cómo el hongo podía variar tanto” explica el catedrático del Departamento de Genética de la UCO, Antonio Di Pietro, que, junto a las investigadoras, Cristina López y Ana Rodríguez, ha descubierto las estrategias que utiliza el hongo para adaptarse.
López, la principal autora del estudio, se metió en el laboratorio para desentrañar la incógnita. “Partimos de una cepa clonal en la que todos los individuos son genéticamente idénticos. A medida que hacemos presión de selección en un medio de cultivo (en las placas de petri del laboratorio) en el van surgiendo mutaciones espontáneas y sólo las beneficiosas son seleccionadas en esa condición ambiental”.

Como explican desde la UCO, tras ese experimento, secuenciaron el genoma en colaboración con otro equipo de investigadores de EEUU, comparando el hongo inicial con el que resultaba tras pasar por distintas placas y haber ido cambiando. “Y ahí es donde surge la sorpresa”, señala Di Pietro. Pensaban que las mutaciones estarían en cambios de unos nucleótidos,
dentro del ADN, como se había descrito previamente en levaduras. Fue así como descubrieron las capacidades con las que cuentan los transposones.
“Se sabía que Fusarium tenía transposones, pero no que eran tan activos”, concreta Di Pietro.
Por eso, el logro de estos investigadores cordobeses es detectar que estos genes ‘saltarines’ son
La uva almeriense esquiva la brutal plaga de mildiu que ha devorado la producción en Huelva
La uva almeriense comenzaba esta campaña con un muy buen pie, con un aumento del 15% de su producción y una calidad extraordinaria, como trasladan desde ASAJA-Almería, incluso llegando a un 20% en zonas como el norte de la provincia o la Ribera del Andarax, arrojando unas perspectivas muy optimistas.
Sin embargo, en el otro lado de la moneda se encuentran los vinicultores onubenses, donde el mildiu ha provocado pérdidas de hasta el 50% del volumen de producción, de acuerdo a Consejo Regulador de la DOP Condado de Huelva, lo que se traduce en una caída de 10 millones de kilos de uva.
“Las pérdidas han sido muy importantes”, ha reconocido el presidente del órgano, Vicente Pérez García, “después de terminar
la recolección, se ha comprobado, desgraciadamente, que el mildiu hizo el daño que ya habíamos previsto”.
La Diputación de Huelva ha asumido el pago del canon de viña (la tasa que el agricultor aporta al Consejo) de esta campaña, y la Consejería de Agricultura se ha comprometido a ofrecer ayudas directas a los viticultores, estimadas en unos 400 euros por hectárea.
los responsables de gran parte de las mutaciones que ayudaban al hongo a adaptarse en su carrera evolutiva. En este experimento causaron más del 70% de las mutaciones encontradas, haciendo en cada una de ellas menos virulenta la enfermedad.
“Encontramos las mutaciones que les permiten tener mucho éxito en placas: crecer más rápido y
producir más esporas. Sin embargo, estos cambios lo hacían menos agresivo en la planta”, profundiza López, “además, considerando que el hongo lleva millones de años adaptándose a la planta, es difícil que en placa se desarrolle una cepa más agresiva. La mejor adaptación posible ya está en la planta”.
Un hongo peligroso Este descubrimiento podría tener una vertiente aplicada, si esas cepas adaptadas a placas con alto crecimiento y poca agresividad “luchan” o neutralizan la actividad de las cepas agresivas en la planta. En cuanto a su valor científico, el hallazgo abre una vía de investigación para quienes trabajan con hongos similares: los distintos equipos de investigación ya tienen la lupa puesta en los trasposones de los organismos que estudian. Fusarium oxysporum es uno hongo patógeno que pone en jaque al sistema agrícola. Afecta a más de 150 cultivos y tiene una alta letalidad, provocando pérdidas millonarias. Este hongo se transforma para adaptarse a nuevos ambientes y huéspedes. Por ejemplo, durante décadas no afectaba a la variedad cultiva plátano, pero surgió una nueva variante del hongo que ataca a este cultivo que antes era resistente.

En el último informe emitido por el organismo andaluz, se muestra un aumento de oídio en algunos de los cultivos, siendo el microclima de los invernaderos muy favorable para su desarrollo
Jessica Valverde
El último informe de la Red de Alerta e Información Fitosanitaria de Andalucía (RAIF) publicado al cierre de esta edición, de la semana 13 a la 17 de octubre, señala la existencia de oidiosis en distintos cultivos del campo almeriense, concretamente en pepino, berenjena y pimiento.
El el caso del pimiento, esta incidencia ha aumentado en comparación al muestreo de la semana anterior (del 6 al 10 de octubre), detectándose síntomas en una de cada cuatro parcelas y en una de cada 50 plantas, mientras que la semana anterior se encontró en una de cada 91 plantas. Desde la RAIF informa que, en
este cultivo, el rango de temperatura de esta enfermedad se sitúa entre 10 y 35 grados centígrados, con un óptimo de alrededor de 26 grados centígrados y la humedad relativa del 70 al 80 por ciento. Siendo el microclima de los invernaderos muy favorable para su desarrollo.
Tanto en berenjena como en pepino su presencia es mínima. En la primera se han detectado síntomas en un número reducido de parcelas, suponiendo niveles que no causan pérdidas en producción.
Mientras que en pepino los síntomas “están siendo testimoniales por el momento”, explican desde la RAIF, que detallan que la temperatura de crecimiento del oídio está relacionada con la humedad y

Hojas afectadas. /FHALMERÍA
con la luz, siendo la temperatura óptima entre 23 y 26 grados centígrados y la humedad relativa del
70 por ciento. Estos datos muestran que la incidencia de oídio en el campo almeriense en este mo-
mento de la campaña es mínima, con pocas fincas y cultivos dañados por este hongo.


Plagas y enfermedades fúngicas
La agricultura intensiva actual se enfrenta a un desafío creciente: producir más con menos, en un contexto de restricciones fitosanitarias, presión de plagas y patógenos fúngicos, y condiciones climáticas cada vez más extremas. En este escenario, la nutrición vegetal avanzada se convierte en una herramienta clave no solo para asegurar el rendimiento, sino también para reforzar las defensas naturales de los cultivos.
En Agran Liquid Technology entendemos la nutrición desde un enfoque bioestimulante, que va más allá de aportar elementos minerales. Nuestro objetivo es activar las rutas metabólicas del cultivo para que pueda responder de manera eficiente frente al estrés abiótico y biótico, reduciendo así la incidencia de plagas y enfermedades.
Nuestras soluciones buscan un equilibrio entre nutrición, activación metabólica y resiliencia del cultivo
Un ejemplo de esta filosofía es DEFEND, una solución innovadora que estimula la síntesis de compuestos de defensa en la planta. Su aplicación refuerza las paredes celulares, activa enzimas relacionadas con la resistencia y favorece la producción de metabolitos secundarios con efecto antifúngico. De este modo, DEFEND no actúa directamente como un fungicida, sino que prepara al cultivo para defenderse por sí mismo, logrando una estrategia preventiva y sostenible.
Este tipo de herramientas resultan especialmente útiles frente a enfermedades fúngicas tan relevantes en el sudeste español como el mildiu, oídio o botritis, donde la presión ambiental y la reducción de materias activas autorizadas obligan al agricultor a adoptar estrategias más integradas. La bioestimulación aplicada a la nu-

trición es, en este sentido, una aliada clave para prolongar la vida útil de los tratamientos fitosanitarios, reducir residuos y mejorar la calidad final de la producción.
El enfoque de Agran no se limita a un producto, sino a un con-
cepto de manejo integral. Nuestras soluciones buscan un equilibrio entre nutrición, activación metabólica y resiliencia del cultivo. Así, no solo se alcanzan mayores rendimientos, sino que se logra una agricultura más ali-
neada con las exigencias del mercado y con los criterios de sostenibilidad.
En definitiva, el futuro de la nutrición vegetal pasa por integrar la bioestimulación como estrategia frente a plagas y enfermeda-
des. En Agran, estamos convencidos de que fortalecer al cultivo desde dentro es la mejor manera de asegurar producciones estables, saludables y competitivas, incluso en un entorno de desafíos crecientes.

Plagas y enfermedades fúngicas
Los resultados han puesto de manifiesto la eficacia de esta técnica ante enfermedades como la botritis
fhalmería
Un estudio llevado a cabo por el grupo de Fitopatología y Microbiología de Suelos del centro Ifapa de La Mojonera (Almería) ha probado que la biosolarización, la práctica agrícola que combina la incorporación de enmiendas orgánicas con la solarización del suelo, es una alternativa a la desinfección con fumigantes que se utiliza para preparar los suelos del invernadero antes de la nueva campaña agrícola.
Los resultados del estudio, publicado recientemente en la revista científica Frontiers in Microbiology, corroboran que esta práctica es una alternativa eficaz y respetuosa con el medio ambiente para el control no químico de las enfermedades del suelo, al tiempo que mejora las propieda-

des físico-químicas y biológicas del mismo. En concreto, el trabajo ha sido desarrollado en Almería durante dos campañas consecutivas de tomate de invernadero, y se ha cen-
trado en observar la respuesta de las comunidades bacterianas nativas del suelo tras llevar a cabo tratamientos de biosolarización con estiércol fresco de oveja durante los meses de verano.
Los resultados obtenidos han puesto de manifiesto la existencia y supervivencia de poblaciones nativas de bacterias antagonistas frente a hongos patógenos (Fusarium, Phytophthora o Botrytis)
tras la biosolarización y a la finalización del cultivo; además de que estas bacterias nativas también mostraron antagonismo frente a hongos de control biológico comerciales.
Así, este hallazgo se ha convertido en especialmente relevante de cara a fomentar suelos naturalmente supresivos frente a enfermedades, a la vez que plantea implicaciones importantes para el uso de productos comerciales basados en microorganismos beneficiosos. Un trabajo en el que los investigadores subrayan que la diversidad funcional de las bacterias nativas puede influir significativamente en la eficacia de los agentes de biocontrol introducidos, lo que manifiesta la importancia de conocer y gestionar adecuadamente la microbiota que, de forma natural, habita en el suelo del invernadero.


Es la cooperativa, por excelencia, de servicio al socio y clientes con suministros, combustible, semillero ecológico y convencional
Almudena Fernández
Las decisiones que los agricultores deben tomar a lo largo de una campaña son muchas y, además, muy determinantes. La elección de la semilla, el uso de uno u otro producto fitosanitario, o acceder a material de primera calidad son cuestiones que, afortunadamente, muchos de los productores tienen más fáciles de la mano de entidades de referencia como es la cooperativa Campoejido.
En una campaña agrícola como esta, marcada por las plagas y la incertidumbre, el asesoramiento técnico de expertos es fundamental; y eso lo pueden encontrarlo en las siete sedes con las que la cooperativa Campoejido cuenta en toda la comarca del Poniente almeriense: en El Ejido, Tierras de Almería, Santa María del Águila, Berja, Adra, Dalías y
“La buena senda de Campoejido se debe al gran apoyo de los socios de la comarca, que ya superan los 3.700”
Balerma; a las que se unirá en un futuro próximo una nueva sede en Roquetas de Mar, donde actualmente cuentan con una estación de servicio. No en vano, la cooperativa ofrece hasta nueve estaciones de servicio.
De esta forma, desde la cooperativa tienden la mano a sus más de 3.700 socios desde antes incluso de plantar. Así ofrecen opciones de financiación a coste 0 como préstamos de campaña y tarjetas bancarias con vencimiento máximo doce meses, además de tarjetas Agrofuertes y tarjetas Univerdes.
Semilleros
A la hora de elegir cultivo, Campoejido les ofrece dos semilleros en los que hacer crecer las plántulas hasta el momento idóneo de llevarlas al invernadero. Por un lado, el semillero de Tierras de Almería y, por otro, el de Dalías.




Entre ambas instalaciones disponen de 66.000 metros cuadrados para atender tanto cultivos convencionales como ecológicos. En ellos, los protocolos para el control de plagas se basan en cerramientos, uso de placas cromotrópicas y otras medidas de biocontrol como el manejo de los insectos auxiliares para dominar las principales plagas y proporcionar así al agricultor un producto completamente sano.
En los semilleros, además, hay una plantilla especializada que, en la época de mayor actividad, alcanza las 70 personas. Además, trabajan distintos tipos de injerto. Una vez la campaña está en marcha, Campoejido ofrece un servicio técnico especializado con profesionales que acompañan durante todo el ciclo de producción, aconsejando sobre los suministros más adecuados para cada tipo de problema que pueda darse en la finca, desde plagas a enfermedades fúngicas.
En definitiva, Campoejido nació en 1979 para unir a los agricultores del campo almeriense y, desde entonces, su evolución ha ido en paralelo con el crecimiento de la agricultura en la provincia, incorporando todo tipo de servicios a sus clientes con el fin de responder a sus necesidades particulares y a las de un sector tan competitivo y exigente como el agrícola. Para esta cooperativa del Poniente resulta fundamental proporcionar un servicio de calidad con un precio competitivo y, hacerlo además, trabajando con las mejores marcas y contando con un equipo técnico y humano plenamente preparado para ofrecer la innovación que demanda el sector agrícola en la actualidad.
En esta línea, el presidente de la cooperativa, Cristóbal Martín, ha subrayado en varias ocasiones que Campoejido ha ido creciendo también en facturación en los últimos años. “Una buena racha que se debe al gran apoyo de los socios de la cooperativa, que continuamente crecen, y también al apoyo de otros clientes de la comarca”, indicó.

Con el aumento de humedad se han generado las condiciones idóneas para la propagación de la botritis o el mildiu
Con las últimas lluvias que han tenido lugar en la provincia de Almería durante el mes de octubre, se han generado las condiciones idóneas para la proliferación de enfermedades fúngicas.
Las hortícolas cultivadas bajo plástico, como el tomate y el pepino, son así unas de las grandes perjudicadas de estas condiciones climáticas, y es que se teme un incremento de enfermedades foliares en las cosechas almerienses, sobre todo del Poniente.
Sin embargo, los cítricos también se pueden ver perjudicados, además de todas aquellas plantaciones al aire libre que existen en la provincia.
En definitiva, Almería se enfrente ahora a un panorama ante el que la RAIF (Red de Alerta e Información Fitosanitaria de Andalucía) ya ha recomendado una serie de medidas para intentar mitigar los efectos adversos de las lluvias de octubre en los cultivos.

Entre ellas, es posible destacar la mejora del drenaje, para evitar encharcamientos; la aplicación de tratamientos fitosanitarios preventivos; el control de la ventilación en los invernaderos; el monitoreo constante de las plagas y enfermedades; o, de igual forma, el ajuste
del riego para evitar excesos de humedad.
Además, desde el organismo se ha animado a los agricultores al uso de variedades resistentes y la aplicación de bioestimulantes pueden contribuir a fortalecer los cultivos frente a estos desafíos.
UUna época donde los agricultores deben estar especialmente atentos a los síntomas de enfermedades como la botritis, que ataca flores, hojas y frutos, generando una pudrición blanda de color gris que puede arruinar cosechas enteras; el mildiu, cuya incidencia
n nuevo estudio, desarrollado a través de la colaboración entre investigadores del Centro de Investigación en Agrigenómica (CRAG) y el Instituto de Agroquímica y Tecnología de Alimentos (IATA-CSIC), ha logrado revelar una estrategia eficaz para la producción de proteínas antifúngicas en plantas; lo que abre nuevas vías para el desarrollo de biofungicidas más sostenibles y seguros para la agricultura. Publicado en la revista ‘Plant Biotechnology Journal’, este trabajo recoge que las AFPs, como PeAfpA de Penicillium expansum y PdAfpB de Penicillium digitatum, son moléculas que tienen
una “amplia gama de hongos patógenos” y son resistentes al calor, las proteasas y condiciones de pH extremas”.
Sin embargo, la investigación, según ha informado el CRAG, lo ha logrado llevar más allá, y es que se ha demostrado que una alternativa para lograr rendimientos altos de estas AFPs reside en dirigirlas a la vacuola. “La principal novedad radica en el uso del gran compartimento vacuolar, habitualmente considerado inadecuado para el almacenamiento de proteínas debido a su entorno lítico, donde las proteínas son propensas a la degradación”, explica Juan José López-Moya, coautor del estudio.
Los investigadores lograron así un incremento notable en la acu-

mulación de proteínas, ya que la producción de PeAfpA se multiplicó por más de nueve veces, mientras que la de PdAfpB por 3,5 veces; en comparación con las construcciones dirigidas únicamente al apoplasto.
Los extractos de plantas enriquecidos con estas proteínas, sin necesidad de una purificación compleja adicional, demostraron una actividad antifúngica equiparable a la de las proteínas purificadas de origen fúngico, tanto en
viene en aumento en las últimas campañas; o el oídio, un viejo conocido del campo almeriense que, aunque su tratamiento ha mejorado, sigue apareciendo cada año cubriendo las hojas con un polvo blanquecino que impide la fotosíntesis y debilita la planta.
ensayos in vitro como in vivo. Hecho que se demostró, además, en unos ensayos con estas proteínas que fueron muy prometedores; como se observó en plantas y frutos de tomate contra Botrytis cinerea, el hongo causante de la podredumbre gris que provoca pérdidas económicas significativas a nivel mundial y, sobre todo, en la provincia de Almería.
Estos resultados sugieren, en definitiva, que las proteínas antifúngicas pueden ser ampliamente utilizadas como fungicidas naturales en la protección de cultivos, incluyendo aplicaciones preventivas y de poscosecha. Un paso crucial hacia una agricultura más sostenible.
Y es que el sistema de expresión transitoria en plantas es rápido, económico y escalable, lo que lo convierte en una plataforma atractiva para la producción de estos biofungicidas verdes. Aunque, si bien es cierto, los investigadores señalan que se necesitarán más estudios del impacto ecológico.






Ecológico

A pesar de dedicar un 5,88% menos en 2024, las previsiones apuntan a un nuevo crecimiento en 2025 y 2026
fhalmería
La apuesta por la agricultura ecológica en Almería ha experimentado en los últimos años un gran aumento que parecía no detenerse. Sin embargo, según señala el último análisis de la campaña hortícola, realizado por la Delegación Territorial de la Consejería de Agricultura, ésta ha sufrido un retroceso en superficie durante 2024, ya que se llevaron a cabo 4.416 hectáreas de hortalizas bajo plástico, lo que supone un 5,88% menos que en 2023.
Durante la campaña anterior, el cultivo ecológico reunió 4.692 hectáreas, mientras que en esta última campaña se dedicaron 276 menos debido a, según la propia Delegación, los altos precios de las hortalizas del cultivo convencional, la falta de medios para luchar contra plagas y enfermedades, los bajos rendimientos y el alza de costes en ecológico.
Estos factores han provocado, de esta forma, que algunos agricultores decidan abandonar este método, aunque siguen siendo minoría; y es que Almería se afianza cada año como referente en agricultura ecológica y ya representa el 80 % del total andaluz en cuanto a hortalizas bajo plástico; con previsiones desde la Delegación de que en 2025 se crecerá de nuevo hasta las 4.430 hectáreas (+0,32%), y en 2026 lo hará hasta las 4.510.
Por cultivos, el tomate ha repetido como líder indiscutible de la provincia gracias a sus 1.943 hectáreas. A este, le sigue el pepino, con alrededor de 753 hectáreas; el pimiento, que ya alcanza las 709 hectáreas; y el calabacín, con 443 hectáreas.
Más lejos se quedan la sandía, donde se llevaron a cabo 399 hectáreas ecológicas; la berenjena, con 89 hectáreas; y la judía y el melón, con sus 44 hectáreas.
Unos datos que, teniendo en cuenta los recogidos durante los últimos 7 años, demuestran el crecimiento del cultivo ecológico en Almería, tanto en producción como en superficie. Pasando así de las 3.169 hectáreas de 2018, hasta las 4.500 que se rondan des-


de 2022 y que señalan una estabilización en el orgánico almeriense.
Contexto nacional
Al igual que ha ocurrido en 2024 en Almería, el total del territorio español también ha disminuido su superficie ecológica hasta las 2.944.941 hectáreas. Una cifra inferior a 2023 en 46.940 hectáreas, pero que continúa situando a España como primer país comunitario en extensión bajo esta modalidad agrícola.
Según el Ministerio de Agricultura, Pesca y Alimentación y sus datos “aún provisionales” del informe ‘Estadísticas de Producción Ecológica en España 2024’, “aunque se trata de 46.940 hectáreas menos, su peso sobre la superficie agraria útil total cultivada en España ha aumentado 2,33 puntos hasta el 12,31 %, debido al mayor descenso de ésta”.
En definitiva, una reducción de superficie ecológica que se ha localizado mayoritariamente en Andalucía, Castilla-La Mancha y Comunidad Valenciana; pero que ha visto cómo las hortalizas frescas han incrementado sus datos en un 1,2%.


Ecológico

La nueva gama de productos de la multinacional almeriense supone una apuesta firme por la protección vegetal sostenible y se estrena con un biofungicida de contacto respetuoso con la fauna auxiliar y libre de siliconas
fhalmería
Vellsam Materias Bioactivas ha dado un paso decisivo en su estrategia de innovación con el lanzamiento de Xtrem, una nueva línea enfocada en el biocontrol. Esta gama de productos supone una apuesta firme por la protección vegetal sostenible, inaugurada con su primer lanzamiento: Xtrem RED, un biofungicida de contacto libre de siliconas y respetuoso con la fauna auxiliar.
El nuevo producto de la compañía almeriense se caracteriza por una formulación basada en una sustancia activa con un modo de acción innovador, diseñado para reducir y controlar la severidad de las plagas. Además, incorpora una estrategia antirresistencia integrada y es plenamente compatible con los sistemas de agricultura sostenible.
Durante los últimos meses, la compañía ha llevado a cabo ensayos en distintos cultivos de la provincia de Almería, entre ellos, pimiento, pepino y tomate, en zonas donde se habían detectado focos virulentos de plagas. Los resultados obtenidos son especialmente relevantes, ya que a medida que se aplicaban los tratamientos, las plantas mostraron un notable incremento en vigor y crecimiento, sin síntomas de endurecimiento o empaliñamiento, efectos secundarios comunes en otros productos a base de siliconas.

También se han realizado pruebas en plantaciones de cítricos y almendros, donde se ha observado un incremento significativo en el rendimiento productivo tras la aplicación de Xtrem RED. Los productores han destacado la mejora visible en el vigor y la apariencia de los árboles, alcanzando una eficacia del 90% en el

control de plagas, comparable a la de otros productos ya consolidados en el mercado.
“La innovación continúa siendo nuestro eje central y seguimos trabajando cada día en nuevas líneas de investigación con el objetivo de responder a las necesidades específicas de cada cultivo”, ha señalado María Cas-
tillo, directora de Marketing de Vellsam Materias Bioactivas. Xtrem RED actúa como un elicitor biológico, activando los mecanismos naturales de defensa de las plantas y demostrando eficacia desde el primer tratamiento. Entre sus principales beneficios destacan ser un producto de residuo cero, la revitalización de
las plantas y el desarrollo de nuevos brotes limpios, su efectividad desde el primer pase o su respeto por la fauna auxiliar. Su aplicación por contacto y su máxima eficacia a pH neutro completan las ventajas de este producto que inaugura una nueva etapa en la protección vegetal sostenible.



La técnica de la solarización, muy utilizada en los invernaderos con producción ecológica, es eficaz para la desinfección del suelo, pero presenta el inconveniente de que afecta a gran parte de su vida microbiana beneficiosa.
Si no se hace nada para corregirlo, las raíces del nuevo cultivo se encontrarán inmersas en un suelo pobre y sin apenas biodiversidad. En consecuencia, las raíces serán más débiles y la planta más vulnerable a las enfermedades. Para evitar esa asociación entre suelos empobrecidos y plantas vulnerables es necesario recuperar la vida beneficiosa del suelo antes de iniciar el siguiente ciclo de cultivo.
Trianum de Koppert es la opción más eficaz para comenzar la campaña con un cultivo fuerte y un suelo sano. Trianum es un poderoso fungicida biológico que garantiza la máxima protección contra los patógenos del suelo. Este producto natural es recomendable aplicarlo por primera vez en la plántula del semillero, y posteriormente realizar una segunda

aplicación en la finca en el momento del trasplante. Su aplicación vía riego es muy sencilla.
Cepa muy agresiva
El secreto de Trianum es la cepa T-22 de Trichoderma harzianum, patentada por Koppert y una de las pocas cepas de Trichoderma con registro europeo para su venta y con autorización para su uso en agricultura ecológica. La exclusiva cepa T-22 de Koppert es muy
eficaz en todo tipo de suelos. A diferencia de otras cepas comerciales, la T-22 tiene el mayor rango de temperatura en suelo por permanecer activa entre los 8 y los 30 grados. Es en ese intervalo cuando germinan sus esporas y la T-22 despliega toda su acción protectora frente a patógenos. Una de las características que mejor definen a esta exclusiva cepa es que su agresividad natural hace que en un tiempo récord co-
lonice el sistema radicular de la planta protegiendo las raíces y destruyendo a los patógenos al mismo tiempo que la cepa se expande, aumentando y prolongando en el tiempo los beneficios de este hongo que es un eficaz fungicida y un valioso protector biológico de las plantas. Se ha demostrado que la Trichoderma T-22 de Koppert es un hongo beneficioso capaz de ejercer una doble función. Actúa como escudo protec-
fhalmería
España se consolida como primer productor de la Unión Europea (UE) en superficie de producción ecológica, con casi tres millones de hectáreas, y sexto del mundo, según se desprende del informe de estadísticas de producción ecológica correspondiente a 2024, publicado en la página web del Ministerio de Agricultura, Pesca y Alimentación.
El documento indica que, al cierre de 2024, la superficie agraria útil destinada a la producción ecológica alcanzó las 2.944.941 hectáreas. Aunque se trata de
46.940 hectáreas menos que el año anterior, su peso sobre la superficie agraria útil total cultivada en España ha aumentado en 2,33 puntos y se sitúa ya en el 12,31 %, debido al mayor descenso de ésta. Los datos, recopilados por las comunidades autónomas, son aún provisionales hasta la validación por la agencia europea Eurostat. La reducción de 46.940 hectáreas en la superficie ecológica se localiza mayoritariamente en Andalucía, Castilla-La Mancha y Comunidad Valenciana. Dentro de la producción vegetal ecológica, destaca el aumento de hectáreas dedicadas a tubérculos y raíces (+7,3 %), plantas co-
sechadas en verde para alimentación animal (+ 2,9 %), hortalizas frescas y fresas (+1,2 %).
A nivel internacional, los estudios subrayan que España es el mayor productor del mundo de aceitunas y uvas ecológicas, y el tercer productor mundial de cítricos ecológicos.
En cuanto a la producción animal, las actividades ganaderas ecológicas han aumentado un 0,5 % en 2024 con respecto al año anterior, y se situaron en 11.164. Destacan los aumentos en équidos (+17,5 %), caprino para carne (+8,7 %) y ovino (+3,3 %). El informe señala también que el número de cabezas de ganado ha

tor frente a patógenos y previene enfermedades fúngicas de raíz, como Fusarium, Sclerotinia, Rhizoctonia, Phytium y nematodos. Además, actúa como promotor de crecimiento, ya que incrementa la producción de raíces secundarias y produce un mayor crecimiento radicular, similar a un “enraizante”.
Más info en: https://www.koppert.es/novedades-e-informacion/ protege-tus-raices-con-trianum/
aumentado un 3,9 % con respecto al año anterior, una subida liderada por caprino (+7,6 %) y equino (+6,3 %).
La acuicultura ecológica descendió en 2024 un 26,28 % hasta las 3.175 toneladas. Destaca la disminución de producción de esturiones (-66,7 %) y mejillones (-28,3 %). Sin embargo, la producción de ostras se incrementó en un 45,4 %.
El número de operadores de producción ecológica registrado en 2024 fue de 62.621, el 2,8 % menos que el año anterior. También descendió un 2,6 % el número total de actividades, 66.687 en total.
En cuanto a las actividades industriales ecológicas registradas, también hubo un descenso de un 3,4 %, hasta los 11.498, tanto las relacionadas con producción vegetal como animal.

La empresa mostró cómo monitoriza la humedad del suelo con tecnología avanzada y ajusta la irrigación en función de los datos obtenidos
La próxima Environmental Sustainability Solution (Solución de Sostenibilidad Ambiental, ESS por sus siglas en inglés) de GLOBALG.A.P. ha pasado por más de treinta estudios de gabinete en 15 países. Hortofrutícola Topi, S.A., organización de productores en Murcia, compartió su experiencia tras participar en esta fase clave del proceso de elaboración de normas de GLOBALG.A.P.
“Estamos entusiasmados por formar parte de esta interesante colaboración de partes interesadas”, afirmó Antonio Caballero Morote, productor de Hortofrutícola Topi.
“Esperamos desarrollar medidas de biodiversidad innovadoras y viables para seguir mejorando la sostenibilidad en nuestras fincas y hacer estas medidas visibles para nuestros clientes”, indicó Antonio Caballero Morote.
Productividad y biodiversidad, de la mano Según Hortofrutícola Topi, las metas de biodiversidad de la ESS son muy relevantes para los productores actuales. Al incorporar nuevas tierras al cultivo, se requieren enfoques innovadores como los que plantea la ESS. Además de reservar espacios sin producción para la conservación, la solución ofrece métodos para enriquecer la biodiversidad en suelos en producción sin afectar el rendimiento de las fincas.
Un principio central de la ESS es la colaboración entre productores para compartir innovaciones en sustentabilidad, que también sirve para la continua mejora de la ESS. Como ejemplo, Hortofrutícola Topi mostró cómo monitoriza la humedad del suelo con tecnología avanzada y ajusta la irrigación en función de los datos obtenidos.
El ensayo también puso en evidencia la importancia de las métricas para monitorear el impacto de las buenas prácticas en el campo y respaldar de esta forma el proceso esencial de mejora continua.

Ensayo llevado adelante por Hortofrutícola Topi SA. /FHALMERÍA
Retroalimentación del campo
Los productores de Hortofrutícola
Topi señalaron la dificultad de evaluar la interacción de sus fincas con otros usuarios de agua a nivel de cuenca, dada la diversidad de marcos institucionales sobre el uso del agua, y dada el nivel de comunicación requerido con terceros, que puede distraer de la operación diaria. También pidieron aclarar qué espera la ESS respecto a la pérdida de especies, ya que cada finca alberga especies distintas en diferentes cantidades. En el ámbito minorista, existe interés en alinear las acciones de los productores con las estrategias de los distribuidores. Se espera
cultivar una colaboración estrecha entre productores y minoristas para fomentar la sinergia y así reforzar la biodiversidad y la sustentabilidad en la producción hortofrutícola.
Las observaciones recogidas en estos y otros ensayos internacionales se integrarán en los próximos borradores de la ESS, antes de iniciar auditorías de campo previstas para el primer semestre de 2026. Este riguroso proceso de elaboración de normas de GLOBALG.A.P., impulsado por las partes interesadas, busca culminar en una solución de sostenibilidad ambiental de amplia aplicación y reconocimiento global.

Control de humedad y temperatura. /FHALMERÍA

El monitoreo es fundamental. /FHALMERÍA
Noticias
En pocas semanas se iniciará la construcción de Almex, su nueva estación experimental y sede en el antiguo Cortijo Quesada
BASF | Nunhems es una marca referente para el agricultor almeriense y lo va a seguir siendo, con más fuerza si cabe, en los próximos tiempos. La empresa acaba de anunciar la futura puesta en marcha de los trabajos de construcción de su nueva sede en la zona norte de la localidad de El Ejido, donde se levantará su nueva sede y estación experimental en un proyecto denominado ‘Almex’ (Almería Extension).
En este sentido, Francisco González, director General de Nunhems en Iberia, señaló que en el antiguo Cortijo Quesada, en una superficie total de 25 hectáreas, se comenzará a construir “nuestra nueva finca de investigación y desarrollo”, un espacio al que se trasladarán los distintos equipos de BASF | Nunhems que ahora están repartidos en tres ubicaciones distintas en Almería.
En este mismo sentido, adelantó que “Almex será un centro total para nuestro programa de mejora de la empresa. En esta primera fase trabajaremos en unas siete u ocho hectáreas donde estará el edificio social, con todo el personal que rondará el centenar, además de la

construcción de las fincas de media y alta tecnología para desarrollar los distintos programas de mejora” para cultivos de Almería, el resto de la Cuenca Mediterránea o incluso México.
Plazos
Esta nueva estación de BASF es un proyecto que lleva gestándose desde el año 2012, cuando se adquirieron los terrenos de esta conocida finca ejidense. Al fin, tras
distintas visicitudes burocráticas, el proyecto ya cuenta con todos los permisos necesarios para iniciarse en breve. De hecho, Francisco González auguró que en enero de 2026 se construirá la rotonda que dará acceso al centro Almex, como paso previo a la colocación de la primera piedra de una infraestructura que, confían, pueda estar finalizada para principios del año 2028. “Este proyecto supone para BASF mejorar sus-
fhalmería
Las asociaciones ASAJAAndalucía y ECOHALAndalucía han remitido una solicitud a la Consejería de Agricultura para reclamar la puesta en marcha de medidas urgentes que incentiven el uso de rafia biodegradable en la agricultura intensiva bajo invernadero. Aseguran que la situación se ha agravado especialmente en las provincias de Almería y Granada,
donde se han impuesto restricciones al uso de rafia de polímero convencional “lo que está generando bastante incertidumbre y preocupación entre los agricultores del sector hortofrutícola”.
Sobrecoste
La alternativa biodegradable, aunque presenta beneficios pues facilita el tratamiento de los restos de la cosecha, supone un sobrecoste que muchos agricultores (especialmente aquellos que no
cuentan con fondos operativos de OPFH) no pueden asumir. Así, recuerdan que en esta situación se encuentra prácticamente el 50% de los agricultores de Almería y la costa de Granada.
Durante el anterior marco del Programa de Desarrollo Rural de Andalucía 2014-2020, se contemplaron ayudas agroambientales que incentivaban en invernaderos el uso de rafia biodegradable con el objetivo de facilitar la gestión de restos vegetales.
tancialmente nuestras instalaciones y prestará aún más cuidado en materia de seguridad y sostenibilidad, donde tenemos un compromiso adquirido con la sociedad. A nivel de investigación, tendremos lo último del sector, tanto en construcción de fincas de media y alta tecnología como en sistemas de digitalización”, añadió Francisco González.
Por el momento, han trascendido algunas de las cifras que sugie-
ren la magnitud de esta futura finca experimental de BASF | Nunhems en el Cortijo Quesada. Así, las oficinas y zonas comunes tendrán una extensión de unos 1.033 metros cuadrados para acoger a los equipos de breeding, ventas y marketing. Además, se contempla la visita de responsables de supermercados a este espacio donde puedan realizar sus catas.
Hasta completar las casi 8 hectáreas (de un espacio total de 25) se habilitarán distintas estaciones de mejora donde se implantarán importantes medidas de seguridad e higiene y distintos puntos de desinfección.
Por otro lado, la sostenibilidad será en Almex una premisa innegociable. Así, se contempla la recuperación del 100% del agua de riego de los cultivos hidropónicos, la instalación de placas solares o la construcción de un embalse de recogida del agua pluvial para su reutilización.
De esta forma, con la construcción de esta nueva finca de investigación y desarrollo, BASF | Nunhems deja clara su apuesta por El Ejido como epicentro de la agricultura almeriense. Más aún, la sede social de Nunhems pasará de estar en Valencia a estarlo en Almería a finales de este año.

Noticias
Los expertos prevén que el incremento de la humedad relativa y los cambios de temperatura típicos del otoño provoquen una aparición de enfermedades fúngicas en los cultivos de hortícolas. Araw y Xanilo 45 WG destacan como dos herramientas eficaces dentro de la estrategia de control de la empresa SIPCAM Iberia.
A pesar de que el inicio de la estación de otoño ha sido cálido y seco, se predice un aumento acusado de la humedad relativa en los invernaderos de la provincia, favorecido por los rocíos matinales y las oscilaciones térmicas entre el día y la noche. “Este escenario va a propiciar la aparición del oídio, el mildiu y la botritis, enfermedades fúngicas que más merman las cosechas en cultivos bajo invernadero.
Menor calidad y producción
El oídio, fácilmente reconocible por el polvo blanco que cubre hojas, tallos y frutos, reduce la capacidad fotosintética, provoca amarilleos, deformaciones y caída prematura de hojas, lo que repercute directamente en la producción y calidad de los frutos.
“Araw, con su formulación microencapsulada, cuenta con registro en todos los hortícolas para el control de oídio y botritis, además de estar certificado para cultivo ecológico”
Mientras que el mildiu destaca por sus manchas amarillentas que se vuelven pardas o necróticas cuando la enfermedad evoluciona provocando una marchitación y caída de las hojas. Ocasionan una reducción del rendimiento de la planta y del cultivo, incluso abortos flo -

rales y de frutos, esclarecen desde SIPCAM Iberia.
La botritis, por su parte, se desarrolla en ambientes con elevada humedad y ventilación insuficiente. Provoca pudriciones grises en flores, tallos y frutos, además de caídas de floración y pérdida de firmeza, lo que limi -
ta la vida comercial del producto y afecta gravemente la rentabilidad. Estas enfermedades encuentran en las condiciones climáticas propias del otoño un caldo de cultivo ideal, especialmente en invernaderos con ventilación reducida o riegos poco equilibrados.
Prevención y control integral
Para hacer frente a este complicado escenario, la compañía de sanidad vegetal SIPCAM Iberia ha propuesto una estrategia basada en dos fungicidas complementarios: Araw y Xanilo 45 WG.
“Araw cuenta con registro en todos los hortícolas para el control de oídio y botritis”, presenta la delegada de Field Marketing. “Se trata de un formulado a base de terpenos naturales que ofrece acción preventiva y curativa, además de un plazo de seguridad bajo”, explica. Está certificado para uso en agricultura ecológica y su formulación microencapsulada mejora la persistencia y reduce el riesgo de fitotoxicidad.
“Xanilo 45 WG, ideal para combatir problemas de mildiu, está registrado en cucurbitáceas de piel comestible, en tomate y otros hortícolas”
Para potenciar su eficacia, el Product Manager de la compañía Jordi Asamar recomienda aplicarlo con un coadyuvante para incrementar su eficacia, además de acompañarlo de otros fungicidas como Sufrevit, que refuerzan la acción preventiva en fases tempranas de la enfermedad.
Por su parte, Xanilo 45 WG está registrado en cucurbitáceas de piel comestible, tomate y otros hortícolas. “Está indicado para el control de mildiu, otra enfermedad habitual en condiciones de humedad elevada. Actúa tanto de forma preventiva como curativa, ofreciendo gran flexibilidad de uso y rápida penetración en el tejido vegetal”, comenta el Product Manager.
Extremar la vigilancia Los expertos coinciden en que esta fase de la campaña exige una vigilancia constante. Mantener un riego equilibrado, evitar condensaciones y ventilar adecuadamente son prácticas básicas para prevenir los ataques. Combinadas con el uso de productos específicos como Araw y Xanilo 45 WG, permiten mantener los cultivos sanos y productivos frente a los desafíos que plantea la humedad otoñal.
Además, el barómetro de AECOC señala que el 74% prevé hacerlo en los próximos 2 ó 3 años
El 53% de las empresas del gran consumo ya emplea inteligencia artificial (IA), especialmente para analizar datos del comprador y para realizar simulaciones de escenarios y objetivos; y un 74% prevé hacerlo en los próximos 2 ó 3 años.
Así lo indica el último barómetro de la Asociación de Fabricantes y Distribuidores (Aecoc), el cual señala que el 60% de los fabricantes ha puesto en marcha nuevos proyectos en 2025, mientras que el 100% de los distribuidores ha afirmado que los ha desarrollado.
Por otra parte, el 35% de las empresas encuestadas aún no utiliza la IA en la gestión por categorías, pero tiene interés en empezar a hacerlo. “Las empresas encuestadas coinciden en que la IA contribuirá a una colaboración más objetiva y basada en evidencias, facilitando la toma de decisiones conjuntas entre fabricante y distribuidor.”, apunta Albert Martínez, responsable de Shopper Marke-

ting en AECOC, en su intervención.
Por otro lado, también están surgiendo algunas dificultades a las que las empresas del sector están teniendo que hacer frente, como la visión del fabricante, la falta de datos y la dificultad para
integrar herramientas, que destacan como las principales barreras que están teniendo que superar. Sin embargo, el sondeo de AECOC confirma que la gestión por categorías se ha convertido en una cultura de trabajo compartida entre fabricantes y distribuidores,
que va más allá de la metodología. Y es que, según la jornada, los proyectos exitosos son aquellos que se han construido sobre la confianza, la transparencia en el intercambio de datos y la visión común de la categoría como motor de crecimiento.
“Más allá de los resultados comerciales, las empresas destacan la mejora en la calidad de las relaciones como los principales beneficios de estos proyectos. La gestión por categorías está ayudando a las organizaciones a transformarse desde dentro”.

La obtentora lleva al mercado variedades de alta producción, calidad excepcional y adaptabilidad en climas exigentes
Semillas Fitó, empresa semillera internacional con más de 140 años de trayectoria, consolida su posición como referente en el desarrollo varietal de sandías gracias a una propuesta genética que combina innovación, sabor, rendimiento y adaptabilidad para los productores y consumidores.
En su catálogo destacan las sandías triploides Taylor y Rhiana, que representan la vanguardia varietal en semillas de su categoría. La sandía Taylor, rayada y de alta producción, resalta por su homogeneidad y calibre óptimo para mercados exigentes, con un cierre pistilar pequeño que reduce las pérdidas y protege la calidad. Su corteza tiene el grosor adecuado para soportar el transporte, preservando la carne interna de lesiones, mientras que en su interior exhibe un color rojo intenso y un sabor dulce con altos grados Brix que deleitan el paladar.
Así mismo, la variedad Rhiana, negra y triploide, está especialmente orientada a trasplantes en invernadero debido a su vigor de planta equilibrado y su alta adaptabilidad a condiciones controladas. Rihana mantiene los estándares de producción y calidad de Taylor y aporta una alternativa diferenciada en sabor y apariencia.
Por otro lado, la compañía ofrece sandías diploides con micro semillas, como Leiva, que desempeña un papel clave como polinizador en cultivos donde se combinan variedades triploides y diploides para lograr un cuaje excepcional y una producción comercial óptima. Leiva destaca por prolongar el tiempo de coincidencia de polinización con las floraciones triploides, maximizando el desarrollo de frutos, además de asegurar calidad interna con un color rojo intenso y un sabor muy agradable. Es especialmente recomendado para trasplantes tempranos, incluso en condiciones de días cortos y temperaturas bajas, garantizando la producción en ambientes delicados.
Innovación constante
En su afán por seguir a la vanguadia de la industria agrónoma, Semillas Fitó ha presentado recien-

temente Amaral, un nuevo polinizador que amplía aún más el periodo de floración coincidente con las sandías triploides, aumentando así la carga frutal y la calidad de los frutos. Amaral, con su tono verde oscuro y micro semillas negras, se recomienda para trasplantes medios y tardíos, aportando un calibre ideal y una apariencia externa clara que evita confusión en destino, facilitando las operaciones comerciales.
“La complementariedad entre sandías triploides (sin semilla) y diploides (polinizadoras) es esencial para asegurar la producción de frutos sin semilla; las triploides no fructifican solas y requieren la presencia de diploides para la polinización, lo que explica su mayor precio en el mercado”, explica Miguel Ángel Fernández Rodríguez, técnico comercial de Semillas Fitó.
Un ejemplo de ello se encuentra en zonas como la provincia de Almería, donde las sandías de Semillas Fitó se injertan en pie de calabaza para tolerar la presencia de Fusarium en los suelos. Este inyector proporciona resistencia a suelos salinos y pesados, condiciones que afectan normalmente a los cultivos.
“Gracias a una continua investigación, en Semillas Fitó garantizamos que nuestras variedades superan diversos ensayos de transporte y conservación postcosecha, asegurando frutos firmes con cortezas suficientemente

Miguel Ángel Fernández con el catálogo de polinizadoras. /A. FERNÁNDEZ
gruesas para proteger la carne de daños, y que pueden mantenerse frescos y sabrosos durante varias semanas tras la recolección”, añade Fernández Rodríguez.
Producción óptima
A su vez, Semillas Fitó focaliza su trabajo en maximizar el rendimiento y la calidad de agricultores que se dedican al cultivo de sandía en invernadero, pues ofrece variedades que cumplen con todos los requisitos para optimizar producciones y elevar la calidad interna de suelos agrícolas de este tipo.
“Genéticamente, buscamos variedades adaptadas a cultivos de invernadero, con plantas equilibradas y que no tengan excesivo vigor para que cuajen perfectamente en condiciones de meses fríos, días cortos y de poca luz o posibles días lluviosos”, dice el técnico comercial de Semillas
Fitó. “Variedades que con días fríos no den problemas de ahuecado de frutos, que no tengan cierres pistilares grandes y que, en esas condiciones extremas, no dejen frutos sin desarrollar para tener una producción óptima en los cultivos”.
“Buscamos variedades donde el número de días que coinciden la flor masculina del polinizador y la flor femenina de la variedad triploide sean mayores para tener así más frutos, más calibre temprano y más calidad interna de los mismos. Al mismo tiempo, en esos días cortos y fríos, buscamos variedades que tengan bastante sabor”, puntualiza Miguel Ángel Fernández.
Maximizar la rentabilidad
El departamento de mejora genética de Semillas Fitó trabaja en estrecho contacto con toda la ca-
dena de valor agrícola (desde agricultores, comercializadoras hasta supermercados) para captar necesidades concretas y desarrollar soluciones varietales que respondan efectivamente. En este sentido, la empresa realiza paneles de cata internos constantes para comparar sus variedades con las de la competencia y adapta sus líneas a las preferencias de consumidores diversos, atendiendo a perfiles que van desde niños hasta personas mayores, para garantizar una experiencia sensorial óptima.
Además, con la intención de mantener un contacto directo y personalizado con sus clientes, el equipo técnico de Semillas Fitó está permanentemente disponible para apoyar a los agricultores en el campo, con visitas personalizadas y charlas en colaboración con comercializadoras.
“Nosotros siempre estamos perfectamente informados de los requerimientos del mercado en cuanto a necesidades de sandía se refiere”, comenta Miguel Ángel Fernández. “Para ello, hablamos con todos los actores de la cadena, es decir, comerciales de comercializadoras, agricultores, plataformas de comercialización y supermercados. Cuando ellos nos transmiten sus necesidades, desde el departamento de breeding se ponen a trabajar buscando soluciones a esto. Y consecuencia de ese trabajo, nos llegan varios números de sandía donde el crop specialist, con ayuda del crop advisor y del global crop coordinator, evalúan el material y ven si cumple con todos los requisitos que nos demandan los actores de la cadena. Si esos requerimientos no son cubiertos, la variedad se elimina”.
Como se puede observar, Semillas Fitó ofrece variedades que cumplen con todos los requisitos para optimizar producciones y elevar la calidad interna, asegurando que los frutos se desarrollen con sabor, firmeza y aptitud para el mercado, incluso bajo condiciones extremas de cultivo. Este compromiso ha posicionado a la empresa como un actor clave en los mercados de España, Portugal y otros países, con ensayos prolongados para definir las fechas ideales de plantación y maximizar el potencial varietal.
La delegación de la OECO recorrió Andalucía, aprendiendo sobre innovación y liderazgo de organismos punteros
fhalmería
El secretario general de Agricultura, Ganadería y Alimentación, Manuel Gómez, inauguraba la primera jornada de la visita de estudio ‘Inmersión en Innovación Agrícola y Economía Social’ en Andalucía, en la que participaban las delegaciones de seis países del Caribe Oriental y la Consejería de Agricultura, Pesca, Agua y Desarrollo Rural de la Junta de Andalucía. Durante su intervención, Gómez destacaba que “esta actividad que tiene como objetivo compartir las experiencias reales sobre cómo la innovación, la economía social y el liderazgo de mujeres y jóvenes pueden revitalizar el medio rural y fortalecer la seguridad alimentaria”. El proyecto ‘EU-CaN: Nutriendo Futu-

ros Juntos’ tiene como finalidad fortalecer los sistemas agroalimentarios sostenibles y la economía social en los países del Caribe Oriental mediante el intercambio de conocimientos con regiones europeas.
La visita, que se ha desarrollado del 20 al 24 de octubre en Madrid, Sevilla, Cádiz y Málaga, ha sido fruto de la colaboración iniciada el pasado mes de mayo durante el Seminario Internacional celebrado en Antigua y Barbuda,
donde la Junta de Andalucía participó como región invitada presentando buenas prácticas en materia de protección social e innovación y economía circular.
Así, los representantes caribeños han podido conocer iniciativas destacadas de innovación y emprendimiento rural impulsadas por la Junta de Andalucía y tendrán la oportunidad de debatir con representantes de la Consejería de Agricultura y organizaciones civiles sobre los retos a los que se enfrentan las mujeres y los jóvenes en el mundo rural a través de las mesas técnicas ‘Mundo Rural en Femenino’ y ‘Jóvenes y Mundo Rural’, en colaboración con las asociaciones AMCAE-Andalucía y COAMUR.
También conocieron el programa Andalucía Open Future, una iniciativa público-privada de
la Junta de Andalucía y Telefónica que apoya la aceleración de startups innovadoras en el ámbito tecnológico y también agroalimentario.
El grupo se desplazó posteriormente a Cádiz para visitar los centros del Instituto de Investigación y Formación Agraria y Pesquera (IFAPA) de Chipiona, Rancho de la Merced (Jerez) y El Toruño (El Puerto de Santa María). El tour finalizó el 24 de octubre, cuando conocieron el Sistema Importante del Patrimonio Agrícola Mundial (SIPAM) de la Uva Pasa de Málaga en la comarca de la Axarquía. Las delegaciones participantes pertenecían a la Organización de Estados del Caribe Oriental (OECO) y representaban a Antigua y Barbuda, Santa Lucía, San Vicente y Granada, Dominica y San Cristóbal y Nieves.

Noticias
IQV Agro España, bajo el sello Cerestia, amplía el alcance de este insecticida sistémico que acaba de obtener el registro oficial para su uso en tomate de invernadero, ofreciendo una herramienta de control eficaz y segura
Carlos Gutiérrez
El cultivo de tomate bajo abrigo es uno de los pilares de la agricultura almeriense. Su calidad, continuidad productiva y capacidad de exportación lo convierten en un emblema del modelo intensivo sostenible del sureste español. Sin embargo, la presión de plagas sigue siendo uno de los principales desafíos para los productores. En este contexto, IQV Agro España, bajo el sello Cerestia, amplía el alcance de su insecticida sistémico YOROI®, que acaba de obtener el registro oficial para su uso en tomate de invernadero, ofreciendo una herramienta de control eficaz y segura.
Solución adaptada a la realidad del invernadero almeriense
Las condiciones de temperatura, humedad y manejo de los invernaderos del sudeste peninsular crean un entorno ideal para el desarrollo pulgones o de mosca blanca, especialmente durante los ciclos otoñales y primaverales del tomate. Esta plaga, además de afectar al vigor vegetativo, provoca melaza y transmite virus que pueden comprometer la producción y la calidad del fruto. Frente a este reto, YOROI® se posiciona como una solución sistémica de nueva generación, persistente y equilibrada con el ecosistema del invernadero. Su registro para uso exclusivo en tomate de invernadero refuerza su papel como aliado estratégico para los agricultores que buscan eficacia sin renunciar a la sostenibilidad.
Modo de acción: protección desde el interior de la planta
YOROI® actúa de forma sistémica y translaminar, penetrando rápidamente en los tejidos del tomate. Su mecanismo de acción se basa en la interferencia con la transmisión nerviosa de los insectos plaga, generando un efecto de choque inmediato y una protección duradera.

1. Absorción rápida: tras la aplicación, el producto se incorpora con facilidad a la planta.
2. Distribución interna: su movimiento translaminar garantiza la protección incluso de hojas nuevas y zonas menos accesibles.
3. Control prolongado: bloquea la actividad nerviosa de los insectos, provocando parálisis y muerte. El resultado es una reducción drástica y sostenida de las poblaciones de mosca blanca, con un impacto mínimo sobre los enemigos naturales presentes en el cultivo.
Datos técnicos y condiciones de uso YOROI® está recomendado para el cultivo del tomate, exclusivamente en invernadero, y cuenta con una gran efectividad ante plagas como pulgones, chinches y moscas blancas (Aleyrodidae). Cabe destacar que la dosis recomendada es de 25/50 g/ha y que la dosis máxima es de 250 g/ha. Es importante destacar también que el número máximo de aplicaciones es de 2 y que cuenta con un plazo de seguridad de 14 días.

Estas condiciones de uso permiten integrar YOROI® dentro de programas de manejo integrado de plagas (MIP), favoreciendo la rotación de materias activas y la reducción del riesgo de resistencias.
Ventajas agronómicas destacadas
El valor de YOROI® no reside solo en su eficacia, sino también en su versatilidad y adaptación al modelo productivo almeriense. Entre sus principales beneficios destacan:
1. Alta eficacia en condiciones de alta presión de plaga, gracias a
su doble acción sistémica y translaminar.
2. Compatibilidad con otros fitosanitarios y bioestimulantes, lo que facilita su integración en estrategias combinadas.
3. Excelente persistencia de control, reduciendo la necesidad de tratamientos repetidos y optimizando costes.
4. Flexibilidad de aplicación, con un plazo de seguridad ajustado a las necesidades del tomate de exportación.
Gracias a estas características, YOROI® contribuye a mantener el equilibrio biológico dentro del in-
vernadero, un aspecto esencial para los productores que apuestan por la sostenibilidad y la certificación en buenas prácticas agrícolas.
Recomendaciones prácticas para un uso óptimo
Para maximizar los resultados de YOROI® en tomate de invernadero, se recomienda:
1. Aplicar al inicio de la infestación, antes de que las poblaciones de la plaga alcancen niveles críticos.
2. Alternar con insecticidas de distinto modo de acción, especialmente en ciclos largos, para minimizar el riesgo de resistencias.
3. Garantizar una cobertura uniforme del cultivo, respetando la dosis indicada y evitando escorrentías.
4. Evitar tratamientos en horas de alta temperatura o baja humedad relativa, para mejorar la absorción y reducir pérdidas.
5. Complementar su uso con control biológico, reforzando el manejo sostenible y la estabilidad del ecosistema del invernadero.
Innovación, sostenibilidad y confianza IQV
Con más de 90 años de experiencia en sanidad vegetal, IQV Agro España, bajo el paraguas de Cerestia, continúa desarrollando soluciones que combinan innovación, eficacia y respeto medioambiental. El registro de YOROI® para tomate de invernadero representa un paso más en el compromiso de la compañía con los agricultores del sureste español, que cada campaña enfrentan condiciones de alta exigencia técnica y comercial.
En un mercado donde la calidad, la sostenibilidad y la seguridad alimentaria marcan la diferencia, YOROI® ofrece al productor una herramienta sólida, moderna y alineada con las nuevas demandas europeas.
Para más información técnica o recomendaciones específicas, puede consultarse la web oficial: www. iqvagro.es
Descubre cómo CERESTIA impulsa el futuro de la agricultura con soluciones integradas, sostenibles e innovadoras: www.cerestia. com.
Jessica Valverde
Acomienzos del mes de octubre la Comisión Europea aprobó la ampliación del plazo para la obligatoriedad del cuaderno digital para los fitosanitarios durante la reunión del Comité Permanente de Plantas, Animales, Alimentos y Piensos (SCoPAFF) sobre la legislación fitofarmacéutica.
Previsto para que fuese obligatoria su puesta en vigor el 1 de enero de 2026, ahora los miembros de la Unión Europea tendrán hasta el 1 de enero de 2027. Una noticia que celebra el sector agrario europeo y, desde ASAJA, apuntaron que este avance ha sido posible gracias al intenso trabajo de representación y presión llevado a cabo dentro de Copa-Cogeca, donde ASAJA ostenta la vicepresidencia del Grupo de Trabajo de Sanidad Vegetal a través de Miguel Minguet.
De hecho, señalan que hace seis meses la Comisión consideraba “poco factible” aprobar un retraso de un año en la entrada en vigor de esta obligación. Sin embargo, la labor de lobby conjunta de Copa-Cogeca y ASAJA ha conseguido revertir esta postura, logrando que se introduzca una cláusula de flexibilidad que proporciona seguridad jurídica y margen de adaptación a los agricultores profesionales de toda la Unión Europea.
Tras este resultado en el SCoPAFF, ASAJA exigió al Go-

bierno de España que adoptase formalmente esta prórroga y se acogiese a la posibilidad de retrasar la obligación hasta 2027.
No obstante, la organización reclamó un aplazamiento indefinido de la medida hasta que existan garantías reales de transición, con condiciones adecuadas para su aplicación en el medio rural.
ASAJA advirtió además de que no todos los agricultores disponen de conexión a Internet suficiente, especialmente en zonas rurales con brecha digital, ni cuentan con el asesoramiento ni la formación necesarios, especialmente entre los agricultores de mayor edad. Además, la orga-
nización recuerda que esta obligación no puede suponer una carga administrativa adicional para los productores.
Desde ASAJA indican que este es un paso muy importante para reducir la incertidumbre del sector sobre este asunto e igualmente debe ir seguido de un desarrollo práctico del contenido de la reglamentación europea, que en el caso español se ha planteado con una carga administrativa compleja e inasumible para las explotaciones (tipo de formato electrónico, plazos de comunicación de datos, etc.) que se debe evitar de cara a su futura implementación.
‘DemoFarm

J. V. S.
El proyecto ‘DemoFarm Andalucía’ de la Consejería de Agricultura, Pesca, Agua y Desarrollo Rural ha estrenado una nueva web con la que los internautas podrán encontrar más fácilmente la información que les interese, siendo esta más visual e intuitiva.
Otra de las novedades es su avance en interactividad, ya que, entre otros contenidos, recoge videos explicativos e imágenes que ofrecen información de utilidad para los agricultores y ganaderos, así como calendarios que les permiten estar al día de las jornadas demostrativas programadas a lo largo del año.
Objetivos del proyecto ‘DemoFarm Andalucía’ es una iniciativa público-privada liderada por la Junta de Andalucía en la que participan los agricultores y ganaderos creando una red de explotaciones colaboradoras donde es posible poner en práctica y evaluar diferentes soluciones tecnológicas que ya se encuentra en el mercado. Hasta la
fecha, se han realizado más de 30 jornadas de campo demostrativas en las fincas colaboradoras en las que han asistido casi 700 personas. La finalidad es conocer su funcionamiento en un entorno real y en diferentes contextos agrarios, ayudando así a los productores andaluces a identificar las prácticas que mejor se adaptan a su explotación y sus necesidades particulares. Aquí radica la importancia del dinamismo del nuevo portal, donde se recopilan las diferentes soluciones digitales que ya se han aplicado en las explotaciones demostrativas de ‘DemoFarm Andalucía’.
Entre las novedades a destacar de la web de encuentra la incorporación de un mapa interactivo de estas fincas que permite a los internautas identificar fácilmente los casos que se asemejan a su explotación en actividad productiva y en variantes tan relevantes como el clima. A través del portal se puede acceder también a fichas técnicas, vídeos formativos e información sobre las herramientas digitales instaladas, entre otras funcionalidades de gran utilidad.

Noticias
DFrancisco Lirola
os investigadores de la Universidad de Almería (UAL) buscan soluciones para poder sacar adelante cultivos agrícolas en Marte.
Juan Mota, catedrático de Botánica, y Encarna Merlo, profesora titular de Fisiología Vegetal, participan en este estudio, junto a la Universidad de Alcalá, del CSIC-CMCNB, la UNED, del Centro de Astrobiología (CAB) y de la Universidad de Alicante, intentando trasladar la experiencia de la flora gipsícola terrestre a los planes de colonización espacial. Los resultados de sus últimos avances han sido publicados en la revista Life Sciences in Space Research, título del trabajo, ‘Gypsophytes and the Use of Martian Gypsum: A Review of Their Potential for Agriculture on Mars’ (Gipsófitas y el uso del yeso marciano: Una revisión de su potencial para la agricultura en Marte´, en español). Y es que este material podría ser la clave.
De tóxico a fértil
Como explican desde la UAL, el principal obstáculo para la agricultura en el ‘planeta rojo’ “es la presencia de percloratos en el regolito marciano, compuestos

tóxicos para la mayoría de las plantas terrestres”.
Por eso, el equipo de científicos se ha centrado en la idea de usar el yeso marciano y plantas gipsófilas, o especies que viven en suelos ricos en yeso, como en el sureste peninsular, para superar la toxicidad del suelo marciano.
El objetivo de hacer crecer y cultivar plantas en Marte está más cerca ahora gracias a este grupo de trabajo liderado por el doctor Miguel de Luis, del Departamento de Ciencias de la Vida de la Facultad de Ciencias de la Universi-
dad de Alcalá. Respecto a los dos investigadores de la UAL, ambos cuentan con un profundo conocimiento del ecosistema gipsícola ibérico, sobre todo gracias a su sólida trayectoria en el estudio de la vegetación que prospera sobre yesos, un tema sobre el que han publicado extensamente a lo largo de su carrera. Así, han convertido su experiencia en Almería en un trampolín para la investigación astrobiológica.
Uno de los tres ejes clave relaciona el yeso en la Tierra y en Marte. Este material es un mineral
La Junta respalda a los grupos operativos de innovación con ayudas de 18 millones
El Consejo de Gobierno ha tomado conocimiento de la nueva convocatoria de ayudas de la Junta de Andalucía para respaldar la ejecución de proyectos de innovación que desarrollan los grupos operativos andaluces. Para 2025, se destinan 18 millones de euros para impulsar la modernización y competitividad del sector agroali-
mentario fomentando la colaboración entre productores (agricultores y ganaderos), centros de investigación, empresas y otros agentes del medio rural.
Las ayudas cubrirán los gastos de personal de los grupos operativos que ejecutan proyectos relacionados con alguno de los eslabones de la cadena agroalimentaria o forestal y que buscan iniciativas que persiguen la creación de valor añadido relacionado con la inves-
tigación y las prácticas agrarias y forestales; la conexión de agentes de innovación y proyectos; ; o la información a la comunidad científica sobre las necesidades de investigación en estos ámbitos.
Las subvenciones se enmarcan en el Plan Estratégico de la Política Agraria Común (Pepac) 2023-2027 y cuentan con la cofinanciación del Fondo Europeo Agrícola de Desarrollo Rural (Feader).
abundante tanto en la Península Ibérica como en el ‘planeta rojo’, y los investigadores proponen buscar y utilizar yacimientos de yeso marciano libres de percloratos en regiones polares como Olympia Undae, donde vientos y vórtice polar podrían haber impedido la acumulación de contaminantes. Otro de ellos es el de plantas ‘Preadaptadas’, explicando que la clave está en las gipsófitas, ya que han desarrollado adaptaciones genéticas únicas para sobrevivir en las condiciones extremas y áridas de los suelos de yeso.
Estas adaptaciones, estudiadas en detalle por el grupo de la UAL, se consideran preadaptaciones útiles para su cultivo en un hábitat controlado en Marte. Desde ahí se llega al tercer eje, el de la “candidata estudiada”. En ese sentido, el artículo destaca a Gypsophila struthium subsp. struthium, una especie de distribución principalmente ibérica y presente en la provincia de Almería, como justo la candidata ideal. Esta planta destaca por su gran resistencia a la sequía y su capacidad de colonizar y facilitar la vida de otras especies, lo que la convierte en prioritaria para la bioingeniería.
El estudio no solo propone el uso directo de estas plantas, sino que sienta las bases para una visión a largo plazo: utilizar técnicas avanzadas de edición genética (CRISPR-Cas9) para transferir las increíbles adaptaciones de las gipsófitas, como su resistencia a la sequía y su eficiencia en el uso de nutrientes, a cultivos comestibles esenciales para la dieta humana en el espacio. En resumen, la investigación llevada a cabo transforma un nicho ecológico local, el de los ecosistemas de yeso del sureste español, en una pieza fundamental de la ingeniería de la vida en el espacio, revalorizando la investigación botánica almeriense para la exploración de nuevos mundos.

Ha contado con la presencia del concejal de Agricultura y Medio Ambiente, Manuel Martínez, y de los coordinadores de ‘Misión Agrotech’ en El Ejido, Fran Antequera y Sandra Molero, así como responsables de asociaciones agrarias, comercialización y empresas tecnológicas
fhalmería
‘ Misión Andalucía - Ecosistema Agrotech’ reunió en el evento ‘Ecosistemas en acción’ a empresarios y emprendedores para avanzar en materia de innovación del agro en El Ejido.
El resultado de esta jornada fue la definición de los retos sistémicos y la creación de grupos de trabajo alrededor de cada reto con el objetivo de asentar las bases para encontrar soluciones e innovaciones para el futuro del agro.
Contó con la presencia del concejal de Agricultura y Medio Ambiente, Manuel Martínez, y de los coordinadores de ‘Misión Agrotech’ en El Ejido, Fran Antequera y Sandra Molero, así como res-

Reunión celebrada en El Ejido. /FHALMERÍA
ponsables de asociaciones agrarias, comercialización y empresas tecnológicas.
Entre las cuestiones que se abordaron se encuentran la ges-
tión integral del agua y regeneración del suelo; innovación agrícola a través de la digitalización del sector; relevo generacional, talento e integración social; gobernan-
za, colaboración y cultura empresarial; y valor y cultura territorial, comunicación y sostenibilidad de la región. El concejal explicó que estos encuentros “están sirviendo

para crear una red de colaboración y crecimiento que permitan al sector avanzar en materia de innovación, digitalización y tecnificación con las mejores soluciones para la agricultura y que permitan garantizar un desarrollo sostenible”.
Esta cita tuvo lugar dentro del calendario de acciones que ha previsto el centro de emprendimiento digital ‘Misión Agrotech’, que tiene como sede, desde el pasado mes de mayo en que fue inaugurado, el Centro de Interpretación de la Cultura Mediterránea de El Ejido. Su creación es fruto del convenio de colaboración entre la Junta de Andalucía, a través de la Agencia Digital de Andalucía (ADA) y el Ayuntamiento de El Ejido.

Semillas Fitó ha organizado un ‘press trip’ este mes de octubre para presentar a la prensa especializada su línea de “innovación colaborativa” con distintas empresas, entre ellas La Cocina de Ideas, un centro de innovación dependiente de Huercasa y con sede en la provincia de Segovia.
Xavier Fitó, director de la División Hortícola de Semillas Fitó, fue el encargado de abrir la jornada recordando el propósito de la empresa: “Aportar riqueza sostenible a toda la cadena agroalimentaria mediante la semilla, gracias a equipos realizados y comprometidos”.
Después, avanzó que Semillas Fitó se focaliza en unos diez hortícolas y distribuye su trabajo en tres canales: Veg Production (para fresco), Veg Value Chain (para la distribución) y Veg Industry (para procesados). Recientemente, además, han creado cinco ‘crops teams’: “Se trata de equipos trasversales que realizan las propuestas de innovación, y que se hacen también de manera colaborativa”, apuntó.
Huella ecológica
En esta línea, se detuvo especialmente en uno de estos proyectos colaborativos de carácter trasversal desarrollado por Semillas Fitó y que le ha logrado, recientemente, el galardón Retina ECO 2025 en la categoría ‘Ecosistema Sostenible’ gracias a la primera metodología específica para medir la huella ecológica de variedades hortícolas. Xavier Fitó aclaró que la empresa está desarrollando, junto al Institut Cerdà, Tecnova y el ISF (International Seed Federation) una metodología para calcular el impacto ambiental a nivel varietal, siguiendo los principios del Product Environmental Footprint (PEF) de la Comisión Europea. “Si el sector adopta como propio este protocolo, que nos gustaría presentar el año próximo, iremos hacia variedades más sostenibles, que consumen menos agua o menos fertilizantes, haciendo el sector más sostenible en general”, manifestó. Por otro lado, puso ejemplos de investigación pensada para los

productores donde la búsqueda de resistencias “ha sido el driver, sobre todo, para cultivos de Almería y Murcia” y recordó cómo el cambio de normativa en genética vegetal en Europa que se avecina podría acelerar los procesos de investigación a corto-medio plazo. Igualmente, en EEUU, colaboran con una empresa de packaging para clarificar en los lineales qué variedad de berenjena es más idónea para cada uso culinario.
Además, el director de la División Hortícola ejemplificó otras propuestas de investigación pensadas para la cadena donde el uso de marcas propias y la creación de clubes de productores han sido la clave para iniciativas tales como el tomate Monterosa, el melón Little Planet o el calabacín Crü, entre otras.
Socio preferente
David García, coordinador global de Large seeds en Semillas Fitó, remarcó el objetivo de la empresa de “ser el socio preferente y estratégico de las distintas agroindustrias”. En este sentido, se refirió a dos proyectos concretos. Por un lado, habló de la ‘Tecnología Seednergic’, que llevan ya siete años desarrollando y que consiste en un recubrimiento específico de la semilla (para cada una de las especies) que favorece el aumento de la absorción de agua y nutrientes, estimula las raíces y minimiza

Con la tecnología Seednergic ofrecen un recubrimiento natural a la semilla para favorecer su comportamiento en situaciones de estrés
el daño por estrés. “Seednergic ha sido clave para el desarrollo de Semillas Fitó en el cultivo de maíz en Turquía aportando valor al mercado y asentando nuestra posición de liderazgo en el sector del freco y el grano”, remarcó David García. Además, la ‘Tecnología Seednergic’ es perfectamente viable para cultivo ecológico.
Har Best es una estrategia clave para el desarrollo de pimiento al aire libre, favoreciendo la recolección ante la escasez de mano de obra
El segundo de los proyectos de investigación colaborativa en el que se centró David García es ‘Har Best’, una estrategia “que ha sido clave para el desarrollo de pimiento al aire libre en distintos países europeos”. “Tenemos un breeding específico para pimiento al aire libre y, con el proyecto que hemos empezado a desarrollar de
la mano de la empresa italiana de maquinaria Guaresi, pretendemos paliar los problemas de mano de obra favoreciendo la recolección mecánica”, añadió.
Cocina de Ideas
Finalmente, Cristina Rueda, directora de Innovación en La Cocina de Ideas; y Carlos Serrano, responsable técnico I+D, remarcaron el fuerte vínculo de La Cocina de Ideas con la industria en base a “una red de colaboradores externos” entre los que se encuentra Semillas Fitó. Son ya ocho años de colaboración entre ambas entidades con 21 proyectos distintos, dos de ellos emblemáticos y centrados en el maíz en grano y en pimiento lamuyo.
En el caso del primer cultivo, estos años de colaboración han permitido sacar varias conclusiones de cada variedad respecto al momento óptimo de cosecha, la evolución de la curva de humedad o los grados brix, así como la variación de diferentes características morfológicas y sensoriales a lo largo de la ventana de cosecha. Por lo que se refiere al pimiento lamuyo, este estudio continuado de la caracterización morfológica y físico química ha permitido evaluar los parámetros más importantes que puedan afectar al rendimiento industrial. En concreto, el estudio sobre el contenido nutricional de las variedades de Semillas Fitó determinó su alto contenido en vitaminas A y C y la buena evolución de este contenido en los diferentes procesos industriales.
A todo ello, Pedro Bautista, director de desarrollo Agroindustria en Semillas Fitó, puso en valor la continuidad de estos estudios de colaboración “que nos aportan resultados más fiables y no puntuales; atendiendo no solo a cuestiones agronómicas sino también a la calidad organoléptica”.
La jornada con la prensa finalizó con una cata a ciegas de las variedades de lamuyo Ramonete y Lobezno, tanto en gazpacho como en tosta con el fin de analizar el color, la textura y el sabor de cada propuesta.
La agricultura repite como el sector con menos accidentes mortales en los ocho primeros meses del año
fhalmería
Los accidentes laborales en el sector agrícola han causado 34 fallecidos en los ocho primeros meses de 2025, uno menos que en el mismo periodo de 2024. Así lo reflejan los datos provisionales de siniestralidad laboral publicados por el Ministerio de Trabajo y Economía Social, donde también se señala que la agricultura ha sido el sector en el que menos accidentes mortales se han producido en los ocho primeros meses del año, frente al de los servicios (180), la construcción (113) y la industria (71).
Durante este periodo se han registrado en total 17.924 accidentes con baja en la jornada de trabajo, el 5,9 % menos. Entre estos, los asalariados que han sufrido accidentes en jornada de

trabajo son 15.812 personas que se dedicaban a la agricultura, la ganadería, la silvicultura y la
pesca, lo que supone también una bajada del 4,9 % menos con respecto a los ocho primeros meses
de 2024. Datos mejorados que se mantienen en el caso de los autónomos, donde otros 2.112 tra-
bajadores del sector agrario han sufrido accidentes con baja, un 12,7 % menos que en el mismo periodo del el año pasado.
Concretamente, entre los fallecidos en la agricultura, 28 han sido asalariados (uno menos que el curso anterior) y 6 autónomos (la misma cifra que entre enero y agosto de 2024).
Del total de accidentes en jornada en la agricultura, la ganadería, la silvicultura y la pesca, 17.678 han sido leves, 212 graves y 32 mortales, mientras que ‘in itinere’ (en el camino al trabajo o de vuelta) ha habido 1.227 leves, 25 graves y dos mortales.
Por último, el trabajador accidentado en jornada se encontraba en lugares agrícolas y de cultivo del suelo en 5.315 casos o en cultivos de árboles y arbustos en 5.470; mientras que existieron 849 sin especificar.


La compañía de sanidad vegetal SIPCAM Iberia recomienda reforzar la prevención y combinar tratamientos específicos para mantener el equilibrio del cultivo
Las condiciones secas de este octubre han favorecido la expansión de araña roja en los cultivos hortícolas. Las temperaturas todavía elevadas, unidas a la baja humedad relativa y a periodos de sequedad dentro de los invernaderos, han creado el escenario perfecto para el desarrollo de estas plagas.
Las consecuencias se han hecho visibles en campo: amarilleo del follaje, pérdida de vigor y reducciones notables de producción. En los casos más graves, las explotaciones han sufrido mermas de cosecha que comprometen la rentabilidad final de la campaña.
Condiciones que han favorecido el brote
Los técnicos coinciden en que la falta de humedad y un riego irregular son factores determinantes. A ello se suman posibles desequilibrios en las poblaciones de enemigos naturales, consecuencia de tratamientos no selectivos.
La conjunción de estos elementos ha permitido un desarrollo rápido de estos ácaros y otras plagas.
Claves para prevenir y controlar
La primera línea de defensa sigue siendo la prevención: “Mantener un riego homogéneo, evitar la sequedad del ambiente y vigilar el envés de las hojas para detectar los primeros focos son claves”, explica la delegada de SIPCAM Iberia Carolina Rodríguez.
Con las primeras apariciones de araña roja, “la intervención química dirigida resulta necesaria”, observa la especialista. “En este sentido, recomendamos una estrategia combinada basada en el uso de los insecticidas y acaricidas Flash UM y Relevant-Oil”. Flash UM actúa sobre las formas móviles de los ácaros tetraníquidos y eriófidos y presenta eficacia frente a vasates en tomate y mosquito verde en pimiento, calabacín, berenjena y pepino.
Por su parte, Relevant-Oil ofrece una excelente protección que afecta a las puestas de los insectos protegiendo a todos los


cultivos hortícolas. No solo hace frente a los ácaros, sino también a pulgones, trips y Tuta absoluta, entre otras plagas. Además de destacar por su acción por contacto, es apto para agricultura ecológica y está exento de LMRs, añade la delegada.
Un otoño de actuación y vigilancia
“Aconsejamos realizar las aplicaciones a primera hora de la mañana, cuando las condiciones de humedad y temperatura favorecen una mejor acción del producto. Dado que ambos actúan por contacto, es esencial asegurar una cobertura completa del follaje, especialmente en el envés de las hojas”, explica la Product Manager Lorena Toribio. Asimismo, se recomienda aprovechar los días cálidos para reforzar la eficacia y alternar los tratamientos según la presión de plaga.
La climatología de octubre confirma que las altas temperaturas siguen fomentando el desarrollo de este periodo crítico para los invernaderos almerienses. Mantener una estrategia preventiva constante, junto con tratamientos selectivos y respetuosos con la fauna auxiliar, será clave para preservar la sanidad y rentabilidad de los cultivos en esta fase de la campaña.


Sakata Seed Ibérica ha presentado en El Ejido a Kairoh, su nueva variedad de calabacín que llega para reforzar la exitosa línea iniciada con Kai. Kairoh comparte las cualidades agronómicas que han convertido a Kai en un referente (como su productividad, estructura compacta y calidad de fruto), pero con una adaptación sobresaliente a las fechas más tempranas y a las altas temperaturas, una demanda creciente entre los productores almerienses. Esta variedad está indicada para trasplantes del 15 de julio al 10 de agosto, mientras que Kai se recomienda del 10 de agosto al 30. “Con Kairoh damos respuesta a una demanda muy concreta del campo almeriense: una variedad con las fortalezas de Kai, pero capaz de mantener todo su potencial en condiciones de altas temperaturas”, ha declarado Cecilio Fernández, responsable de desarrollo de calabacín de Sakata Seed Ibérica.
Según Fernández, “si Kai fue un KO al Nueva Delhi, Kairoh duplica ese KO también al calor, porque es una variedad que fortalece esta adaptación y hace
La nueva variedad es el complemento perfecto de Kai, enfocándose en fechas más tempranas, adaptado a sus condiciones fhalmería

Eque se pueda trasplantar en fechas más tempranas, donde las temperaturas son más altas, manteniendo la resistencia al virus de Nueva Delhi”, ha afirmado Cecilio Fernández.
Además, Sakata sigue enfocándose en lo más importante: la rentabilidad para el agricultor. Kairoh, al igual que Kai, presenta una planta compacta, de estructura abierta, que además de facilitar los tratamientos y la recolección, reduce los costes de mano de obra y entutorado. Esta característica, unida a la alta productividad de la variedad, hacen el cóctel perfecto para garantizar el máximo ren-
dimiento por m2 al agricultor. Los frutos de Kairoh destacan por su color muy oscuro y brillante, su forma cilíndrica y recta, y su mácula y cicatriz pistilar muy pequeñas, características que los hacen ideales tanto para exportación como para mercado nacional.
El equipo técnico y comercial de Sakata ha destacado durante el evento el compromiso de la compañía con el desarrollo de variedades adaptadas a las nuevas condiciones climáticas, que aporten rentabilidad, calidad y estabilidad a los productores almerienses. Kairoh es ejemplo de ello.
l grupo de distribución alemán Edeka ha decidido vender en sus supermercados almendra ibérica en lugar de californiana, con el fin de responder a la demanda de los consumidores de reducir las distancias de transporte y fomentar la sostenibilidad.
Edeka explica que ha apostado por su nueva línea “Herzstücke” de productos con almendra, hecho con almendras europeas en lugar de californianas. Destaca que el cultivo en España y Portugal supone, en comparación con el de Estados Unidos, trayectos de transporte bastante más cortos y una huella de CO2 menor. Además “la producción dentro de la
El Gobierno amplía en 15 millones la línea de ayudas ‘Agroinnpulso’
El Consejo de Ministros ha autorizado hoy la colaboración entre el Ministerio de Agricultura, Pesca y Alimentación y la Empresa Nacional de la Innovación (ENISA), dependiente del Ministerio de Industria y Turismo, para ampliar en 15 millones la línea ‘Agroinnpulso’, que financia empresas emergentes y pymes innovadoras del sector agroalimentario. Esta autorización supone la renovación del convenio suscrito entre ambas instituciones en 2021, que se extenderá hasta el 31 de diciembre de 2035.
El Ministerio de Agricultura, Pesca y Alimentación aportará los 15 millones de euros de su presupuesto a ENISA, que los destinará a la concesión de los préstamos participativos.
‘Agroinnpulso’ es una línea de financiación destinada a favorecer la financiación de los proyectos empresariales de base tecnológica de startups y pymes del sector agroalimentario.
El objetivo de esta línea es mejorar la competitividad de las empresas emergentes, pequeñas y medianas que quieran adoptar tecnologías punteras, así como de aquellas que proveen servicios y soluciones digitales de alto valor, especialmente si contribuyen a favorecer la generación de riqueza y empleo en el medio rural.
Este convenio constata la eficacia de la financiación a las
pymes por parte de ENISA y su importante efecto tractor en el desarrollo del mercado de capital privado, que se debe, principalmente, a las ventajas que ofrecen los préstamos participativos, pensados para fortalecer la estructura financiera de las empresas.
Hasta la fecha, se han aprobado 244 operaciones de la línea ‘Agroinnpulso’ por un importe superior a 40 millones de euros. En conjunto se han movilizado 30 millones de euros de fondos europeos Next Generation y 23 millones del Ministerio de Agricultura, Pesca y Alimentación, a los que se sumarán ahora estos 15 millones que el Consejo de Ministros ha aprobado incorporar para ponerlos a disposición de las empresas interesadas.
Los préstamos participativos de esta línea los pueden obtener las pymes agroalimentarias de toda la cadena de valor que desarrollen actividades innovadoras y de base tecnológica, tanto en sus etapas iniciales como en las de crecimiento. Se presta especial atención a aquellas empresas con capacidad de generar empleo de calidad para jóvenes y mujeres que acometan inversiones necesarias y desarrollen su proyecto empresarial en la creación de nuevos productos, procesos o servicios.
ENISA es una sociedad pública adscrita al Ministerio de Industria, Comercio y Turismo, cuya misión es contribuir a que proyectos viables e innovadores.
Unión Europea está sujeta a estrictas normas medioambientales y sociales, lo que promueve la transparencia y refuerza la confianza de los consumidores”. En 2023, Alemania importó 101.000 toneladas de almendras, procediendo de Estados Unidos el 66% y de España el 19%. En Almería, las principales zonas productoras de almendra

son la comarca de Los Vélez y la del Almanzora, que en los últimos años han padecido campañas des-
iguales y muy mermadas en producción a causa de la sequía persistente.
Noticias
Ha mostrado en Fruit Attraction sus diferentes soluciones para colaborar con una agricultura
FMC Agricultural Solutions ha participado un año más en Fruit Attraction, que con la participación de 120.000 profesionales y de 2.460 empresas expositoras de 64 países, se consolida como epicentro mundial del sector hortofrutícola. FMC ha contado con un moderno y novedoso stand que ha estado siempre lleno de clientes y técnicos de toda España, de diversos países de Europa y del área mediterránea.
FMC ha presentado en Fruit Attraction sus soluciones para diferentes cultivos, fruto de la constante apuesta por la I+D, con el objetivo de mantener en el más alto nivel el lema de la compañía: “Más que protección”, destacando sus soluciones en base a Cyazypyr®, como es Exi-
rel® para cítricos y olivar, las soluciones bioestimulantes como es Accudo®, para hortícolas, o Tripali® como herbicida para cereal. Exirel®, una nueva solución insecticida en base a Cyazypyr®, la potente materia activa de última generación desarrollada por FMC, que se está convirtiendo en una herramienta fundamental en la lucha contra varias plagas, en cultivos claves para nuestros agricultores, como son los cítricos, el olivar o la viña. Exirel® es muy eficaz para el control de una gran variedad de plagas como trips, mosca blanca, pulgón, dípteros, lepidópteros, cicadélidos entre otros, en los cultivos de cítricos, olivo y vid de vinificación. Es eficaz principalmente por ingestión y también por contacto, presentando actividad ovicida, ovi-larvicida, larvicida y adultici-

da, dependiendo de la especie de la plaga a controlar. Accudo® es un bioestimulante para hortícolas formulado con Bacillus paralicheniformis cepa RTI 184, con patente exclusiva FMC. Accudo® es uno de los primeros bioestimulantes desarrollados íntegramente por la compañía, desde el descubrimiento de la cepa, pasando
por el desarrollo del producto, el proceso de ensayos, y la puesta en el mercado. Este bioestimulante ofrece una solución innovadora, eficaz y totalmente natural para luchar contra el estrés abiótico de las plantas, y mejorar su potencial desarrollo desde las raíces, consiguiendo plantas más fuertes, sanas, con mayor producción y calidad.
Por otra parte, Tripali® es un robusto y eficaz herbicida para el control de malas hierbas en todos los cereales que se ha consolidado como uno de los productos de referencia para el control de malas hierbas de hoja ancha en postemergencia en cereal. Su formulación, basada en tres materias activas, le permite controlar más de 60 especies, incluidas algunas de las más problemáticas, como lapa, magarza, cardo, lamium y crucíferas. Además, se ha profundizado en el conocimiento de otras soluciones a base de Cyayzpyr® como Verimark® o Benevia®; soluciones insecticidas a base de Rynaxypyr® como Altacor® 35WG y Coragen® 20SC; los bioestimulantes Amalgerol® y Seamac® OR; o herramientas digitales como la aplicación Arc® farm intelligence.


De cara a optimizar la gestión y el manejo de las fincas, desde la entidad han lanzado la segunda edición del curso de formación en el que el año pasado ya participaron 40 profesionales relacionados con el sector agrícola
Jessica Valverde
Extender el uso de la tecnología en el sector agrícola es uno de los principales retos del momento. A pesar de haber numerosas herramientas y nuevas tecnologías que ayudan a una mejor gestión de las explotaciones agrícolas, no todos los agricultores están receptivos con incluirlas en su rutina diaria. De cara a acercar a los profesionales del campo, tanto agricultores como técnicos, las nuevas herramientas y tecnología con las que pueden contar, Cajamar ha lanzado el curso ‘Tecnología y digitalización para producción de cultivos hortícolas en invernadero’, que este año alcanza su segunda edición.
De esta manera Cajamar no solo trabaja en investigación, sino también en formar a aquellos a los que van destinadas estas herramientas y tecnologías. El encargado del desarrollo de este curso es Juan José Hueso, investigador en la Estación Experimental Cajamar, que ha explicado a FHALMERÍA la gran acogida de este curso, “ya que el año pasado contamos con una alta participación, en total fueron 40 inscritos y una asistencia media a cada sesión de 30 personas”. El éxito de dicho curso ha llevado a que en esta nueva edición los inscritos hayan aumentado, “a la primera sesión han asistido 52 personas”, detalla Hueso.
El objetivo básico del curso es “mostrarles a los agricultores las tecnologías que pueden estar a su disposición para mejorar sus explotaciones”, explica el investigador. Cabe mencionar que este está organizado dentro de las actividades de formación del proyecto AGROTECH-DIH, del que Cajamar es socio, y se desarrolla en la Estación Experimental Cajamar ‘Las Palmerillas’ durante los meses de octubre y noviembre, siendo la última sesión la primera semana de diciembre. Se desarrolla en cinco sesiones en las que se ofrecerá una visión integral de la producción de hortalizas en invernadero, mostrando las herra-

Una de las sesiones del curso. / FHALMERÍA
mientas y tecnologías disponibles para optimizar la gestión y manejo de las explotaciones.
Por sesiones
La primera sesión está destinada a trabajar en herramientas para la gestión de la explotación, en particular sobre el cuaderno digital, que lleva varios años instaurándose en el campo y que pronto será obligatorio.
La segunda sesión está enfocada en las herramientas destinadas a riego y fertilización, “es el ámbito en el que la tecnología está más madura”, afirma Hueso, es por ello que ahora “se encuentra en fase de transferencia, de que los agricultores vean su utilidad”. Entre estas se encuentran aquellas destinadas a la ayuda a la toma de decisiones o el uso de diferentes sensores, “en Cajamar tenemos varios ensayos en marcha y los participantes del curso van a visitarlos para ver cómo funcionan”, detalla Juan José Hueso. Además de ver su funcionamiento, el curso cuenta con otro apartado en el que los asis-
tentes pueden comprobar cuáles son los resultados del uso de esas herramientas, es decir, los beneficios que pueden conseguir en sus fincas gracias al uso de la tecnología.
La gestión y control del clima es la protagonista del cuarto bloque. “En este ámbito llevamos mucho tiempo trabajando y hemos comprobado que a los agricultores les cuesta trabajo adoptar esta tecnología específica”, detalla Juan José Hueso, que además hace hincapié en que este tipo de tecnología es “clave”, ya que una buena gestión y control del clima en invernadero “nos va a condicionar mucho a que tengamos una mayor producción y a su calidad”. Entre las herramientas que se van a mostrar a los participantes en el curso se encuentran distintos sensores para el control y gestión de la ventilación, así como pantallas de sombreo. “Estas técnicas ya están maduras, pero hay un problema de implantación por parte del sector”, informa Hueso, que además explicó que, para fomentar el interés por
estas herramientas, se va a llevar a cabo una mesa redonda en la que diferentes agricultores y técnicos, que están trabajando y aplicando estas técnicas, van a
contar su experiencia, con los resultados obtenidos desde que han decidido apostar por estas nuevas tecnologías.
Y finalmente el curso cuenta con un quinto bloque que se encuentra más enfocado a herramientas y tecnologías futuras, como es el de la robotización y mecanización. Concretamente está centrado en temas de predicción de cosecha y visión artificial. Además, “hay algunos temas de robótica que se están estudiando en la Universidad de Almería adaptados a los invernaderos. Aunque estos son proyectos a medio plazo, son de lo más atractivos”, comenta Juan José Hueso. Así, se considera que esta es una de las tecnologías que más pueden interesar al campo de cara a solventar el problema existente con la mano de obra. “Todo lo que sea mecanizar las tareas repetitivas del invernadero es fundamental”.
Es así cómo desde Cajamar apuestan por una agricultura con nuevas herramientas y tecnologías que además de mejorar el trabajo en el campo lo haga más atractivo de cara a las nuevas generaciones, contribuyendo así al relevo generacional.






Las plagas se encuentran fuera de control y en plena expansión hacia otros cultivos, mientras los expertos se reúnen sin coincidir en los caminos a tomar para erradicarlas
El campo almeriense está sufriendo esta campaña las consecuencias de dos plagas que no cesan: el Thrips parvispinus y la araña roja. Sin respuestas efectivas, la situación es cada vez más grave y los agricultores se encuentran indefensos mientras sus cosechas tienen que ser arrancadas.
Ante la urgencia, la Consejería de Agricultura, Pesca, Agua y Desarrollo Rural de la Junta de Andalucía ya ha celebrado la que ha sido la segunda reunión de la Mesa Técnica de Expertos en Sanidad Vegetal, donde se han reunido más de treinta especialistas para proponer soluciones.
En dicho encuentro se establecieron cuatro temas fundamentales, entre los que se encontraba, en primer lugar, la presentación de un protocolo de gestión de arranque de restos vegetales que se publicará en la Red de Alerta en Información Fitosanitaria. Asimismo, se presentó un protocolo de control biológico en pimiento, realizado por las empresas productoras de control biológico en coordinación con el IFAPA; como también se propuso con argumentos técnicos las materias activas fitosanitarias que se van a solicitar al Ministerio de Agricultura y, finalmente, se estableció colaboración en el control del transporte de restos vegetales.
Sin embargo, según COAG, al término de la misma no se llegaron a poner en práctica “las medidas que el campo almeriense necesita” y que, desde la organización agraria se han reclamado desde hace más de un mes como única solución para amortiguar el impacto de las plagas: la solicitud de autorizaciones excepcionales de las materias activas propuestas por el equipo técnico.
Y es que para el secretario provincial de COAG en Almería, Andrés Góngora, “el ritmo del grupo de trabajo no es el que pide la situación de emergencia actual”, ya que “la detección precoz y la combinación de herramientas como el monitoreo, el control cli-

mático, el uso de fauna auxiliar o productos fitosanitarios compatibles, es una vía eficaz a largo plazo para garantizar la sostenibilidad del modelo agrícola almeriense, pero no es una respuesta adecuada a la inminente necesidad de herramientas que requiere la situación actual”.
El presidente del Colegio Oficial de Ingenieros Técnicos Agrícolas de Almería (COITAAL), Fernando Paniagua, ya advertía al inicio de campaña de la gran incidencia de estas plagas. Sobre todo, de este parvispinus que, con una temperatura de 25 grados, tiene un ciclo biológico de apenas 18 días; por lo que se ha visto beneficiado de un clima que no parece refrescar lo suficiente en octubre.
Desde el COITAAL, y con el objetivo de hacerle frente y reducir el riesgo de propagación, se recomendaba mantener cerramientos sin roturas y cubiertos con malla anti insectos de alta densidad; dobles puertas; realizar destallados y deshojados para mantener la planta abierta; retirar restos vegetales; instalar trampas cromáticas a diferentes alturas; y solarizar al finalizar el cultivo. Medidas que muchos agricultores han llevado a cabo pero que, quizá por el estado avanzado de la plaga, no han logrado mantener a raya al trips.
En el caso de la araña, desde la Junta de Andalucía, también se animaba al productor a eliminar las malas hierbas y restos de culti-

vos, ya que pueden actuar como reservorio de la plaga; tratar las estructuras presentes y el suelo antes de realizar una nueva plantación, además de solarizar en los periodos recomendados por un mínimo de 30 días; proteger los primeros estados vegetativos de las plantas; o tener cuidado para no transportar la plaga con las operaciones habituales que se hacen en el cultivo.
Aunque tampoco parecen surtir efecto en una araña roja que, al igual que el parvispinus, desespera al campo almeriense.
Por todo ello, la situación se alza como una emergencia total para una provincia que, actualmente, no cuenta con las herramientas necesarias para actuar
con eficacia; pidiendo desde las organizaciones agrarias las autorizaciones excepcionales de productos fitosanitarios que erradiquen el problema. Algo que, sin embargo, otros expertos del sector también califican como insuficiente, poniendo el foco sobre el control biológico como única solución.
Sea como sea, el sector se encuentra debatiendo las posibles soluciones a un Thrips parvispinus y una araña roja que están desestabilizando la cada vez más mermada rentabilidad del productor, además de encontrarse en plena expansión hacia otros cultivos a los que, como ya ha hecho con el pimiento, pretende herir de muerte.
Los especialistas recomiendan “respetar el calendario y los ritmos de suelta que han demostrado eficacia histórica”
El Thrips parvispinus se ha convertido en una amenaza creciente para los cultivos hortícolas, especialmente el pimiento. Esta plaga invasora afecta directamente la calidad comercial del fruto y puede poner en riesgo toda la producción si no se actúa a tiempo. En Agrobío son conscientes de que la clave para controlar eficazmente al Thrips parvispinus está en la prevención, instalando depredadores naturales desde el inicio del cultivo. “Optar por tratamientos químicos de forma reiterada y liberar auxiliares como sueltas de “choque” en semanas avanzadas del cultivo, es un error, los insectos ya no tienen tiempo de establecerse y la planta está ya castigada. Esta práctica reduce el éxito del control biológico”, insisten. Por eso, la recomendación de Agrobío es clara: las sueltas deben realizarse desde el inicio, respetando el calendario de liberación que ha demostrado éxito histórico en el pimiento y otros cultivos sensibles como el pepino.
¿Cómo proteger las zonas vulnerables de la planta?
Agrobío ofrece una propuesta que combina una gama adecuada de auxiliares y asesoría técnica especializada. Entre ellos destacan:
• ORIcontrol Cold (Orius laevigatus), el depredador natural más potente contra Thrips parvispinus, seleccionado por su voracidad y resistencia, capaz de consumir una gran cantidad de trips diarios.
• SWIRScontrol (Amblyseius swirskii) y MONcontrol (T. montdorensis), ácaros depredadores que no son un complemento, sino la base fundamental de la estrategia para romper el ciclo biológico de esta plaga.
• POWERMite 3.0, una dieta patentada que alimenta a estos auxiliares directamente sobre la planta, facilitando su establecimiento y multiplicación en las zonas más vulnerables de la planta. La alimentación es un producto estratégico para la instalación temprana

de depredadores y su eficacia durante todo el ciclo.
Además, otros insectos generalistas, como las crisopas (CHRYSOcontrol), así como especies de aparición espontánea (entre ellas ácaros anístidos y trips depredadores como Haplothrips spp., Franklinothrips y Aeolothrips spp.) contribuyen a reforzar el control de Thrips parvispinus. “Este conjunto de aliados ofrece un apoyo adicional para mantener sus poblaciones a raya, especialmente en los picos que se registran en esta época, durante el otoño y el invierno”, insisten desde Agrobío.
Control biológico eficaz de Thrips parvispinus
Para proteger los cultivos y mantener la calidad de los frutos, Agrobío propone seguir estas recomendaciones clave:
• Instalar los depredadores naturales desde el inicio del cultivo, sin esperar a que la plaga aparezca o cause daños.
• Imprescindible observar y actuar sobre los primeros focos.

ORIcontrol Cold y POWERmite 3.0.
• Respetar el calendario y los ritmos de suelta que han demostrado eficacia histórica, especialmente en pimiento.
• No usar químicos como única o primera opción, ni tratar reiteradas veces antes de liberar los auxiliares.
• Asegurarse de incluir ácaros depredadores como SWIRScontrol y MONcontrol, ya que son la base fundamental de la estrategia.
• Utiliza la dieta especializadas
“Para un control efectivo del parvispinus es fundamental que el sector hortícola trabaje unido, aplicando el control biológico desde primavera, y no solo en pimiento, sino también en el resto de cultivos”
POWERmite 3.0 para facilitar el establecimiento y la multiplicación de los auxiliares directamente sobre la planta.
• Fomentar el control conservativo cuidando la biodiversidad funcional para potenciar los enemigos naturales y mejorar el equilibrio del control biológico. Tanto los ensayos de campo y la experiencia respaldan la eficacia de esta estrategia preventiva de Agrobío, quien además cuenta con un servicio técnico especializado y envíos exprés para asegurar una rápida adopción de la solución.
Para lograr un control efectivo del Thrips parvispinus, es fundamental que todo el sector hortícola trabaje unido, aplicando el control biológico desde primavera, y no solo en pimiento, sino también en el resto de cultivos, como cucurbitáceas, berries, cítricos y ornamentales. Esta coordinación entre productores es clave para reducir la presión de la plaga en todos los cultivos afectados y asegurar un manejo sostenible, seguro y duradero de las producciones.

Ante la reducción de las certificaciones permitidas, conocer bien las herramientas que el agricultor tiene es fundamental
Al igual que ocurrió el año pasado, la campaña agrícola 2025/2026 en el Poniente almeriense se ha iniciado con una presencia masiva de araña roja y Thrips parvispinus, dos plagas que afectan principalmente al cultivo del pimiento, que es el que más predomina en esta zona.
Desde que el Thrips parvispinus fuera detectado por primera vez en Almería hace ya 5 años, su incidencia ha aumentado cada vez más, y con ella los daños que puede causar. Así pues, desde el almacén agrícola Fitosur, referente en asesoramiento agrícola en la provincia de Almería, asegura que “la estrategia de control más adecuada se basa en la combinación de productos fitosanitarios compatibles con la fauna auxiliar, introduciendo altas dosis de ácaros depredadores y orius, así como alimentando estos ácaros con Predafix e introduciendo Atheta coriaria en el suelo para cortar el ciclo del trips. Esta es la combinación mediante la cual el agricultor consigue los mejores resultados”.
Control de la araña roja
El gerente de Fitosur, Paco Yélamos, ha comentado a FHALMERIA que “contamos con menos registros fitosanitarios que combatían a la araña roja y ahora estamos padeciendo una mayor incidencia que ocasiona el deterioro de la planta y el fruto”. Ante este problema, el gerente de Fitosur comentó otras soluciones para luchar contra esta plaga en las fincas de pimiento, destacando “la prevención con suelta de auxiliares como el Ablyseius californicus combinado con ciertos productos que hay ahora mismo en el mercado, se puede controlar muy bien esta plaga”.
Asesoramiento
Tal y como explica Paco Yélamos, cada campaña agrícola tiene sus propios problemas, y muchas veces son impredecibles, pero lo importante es combinar las herra-


Insecto depredando un Thrips parvispinus.
mientas que hay y realizar un gran trabajo preventivo.
Más servicios
Otro aspecto importante a desta-
car es que Fitosur ofrece venta al por mayor de sus productos a otros almacenes y empresas del sector. Además, esta empresa de referencia dispone del servicio di-

Daños visibles ocasionados por la araña roja.
recto al agricultor con reparto a fincas, facilitándole su labor diaria. Cabe destacar que todo el que quiera conocer más acerca de los servicios de Fitosur puede contac-
tar al teléfono 950 49 85 10, mandando un correo a info@fitosur.es o bien asistiendo a almacén ubicado en Ctra. Los Alcores, SN Matagorda.
Thrips parvispinus
fhalmería
El Grupo Municipal del Partido Popular en el Ayuntamiento de Adra ha presentado una moción para el próximo Pleno para reclamar al Ministerio de Agricultura, Pesca y Alimentación la autorización excepcional de materias activas fitosanitarias que permitan combatir eficazmente las plagas de araña roja (Tetranychus urticae) y, especialmente, del Trips Parvispinus (Thrips parvispinus), una especie invasora que está causando estragos en los cultivos del Poniente almeriense.
El grupo popular ha advertido de la situación crítica que atraviesan los agricultores del municipio, señalando que en

Adra existen alrededor de 1.500 hectáreas de invernadero y que cientos de familias dependen de
estas explotaciones. Según recoge la propuesta, las pérdidas están siendo devastadoras y los
medios actuales resultan insuficientes para frenar el avance de estas plagas, lo que hace imprescindible que el Gobierno actúe con medidas urgentes y excepcionales.
Los daños, principalmente estéticos, reducen drásticamente el valor comercial del producto, aunque no afectan a su calidad ni a su seguridad alimentaria, lo que deja al agricultor sin rentabilidad a pesar de contar con un producto perfectamente apto para el consumo.
Desde el Partido Popular se reclama que el Ministerio autorice, con carácter excepcional, nuevas materias activas fitosanitarias para combatir estas plagas, ante la falta de alternativas biológicas o químicas viables y suficientes. Asimismo, se solici -
tan medidas económicas urgentes para compensar las graves pérdidas sufridas por los agricultores, tanto por el arranque prematuro de cultivos como por el encarecimiento de los tratamientos fitosanitarios y la reposición de fauna auxiliar.
Competencia desleal
Además, el grupo popular denuncia la competencia desleal que padecen los productores locales frente a los de países terceros, como Marruecos, Turquía o Egipto, que utilizan sustancias prohibidas en la Unión Europea y cuyos productos llegan al mercado europeo, mientras que los agricultores locales ven reducidas sus herramientas de defensa frente a plagas, bajo una normativa cada vez más restrictiva.





Thrips parvispinus
La globalización del comercio agrícola ha facilitado la presencia de plagas exóticas, y frente a este escenario, se requieren soluciones fitosanitarias eficaces y sostenibles
El control de plagas invasoras como Thrips parvispinus y Scirtothrips sp. representan un desafío creciente en los sistemas agrícolas del área mediterránea. En este contexto, Spintor® 480 SC, formulado a base de Qalcova™ active, se posiciona como una herramienta eficaz, sostenible y con un perfil toxicológico favorable. Este artículo presenta las características técnicas, modo de acción, eficacia y ventajas de Spintor® 480 SC en programas de manejo integrado de plagas (IPM) y agricultura ecológica.
La globalización del comercio agrícola ha facilitado la diseminación de plagas exóticas, como Thrips parvispinus y Scirtothrips sp., que han invadido cultivos en el arco mediterráneo español. Estas especies, al no tener enemigos naturales establecidos, representan una amenaza significativa para la producción hortofrutícola.
Frente a este escenario, se requieren soluciones fitosanitarias eficaces, selectivas y compatibles con los estándares de sostenibilidad actuales.
Spintor® 480 SC y Qalcova™ active
Spintor® 480 SC es un insecticida de origen natural desarrollado por Corteva Agriscience™, cuyo principio activo, Qalcova™ active, pertenece a la clase química de los spinosines. Este compuesto fue descubierto a partir de la fermentación de Saccharopolyspora spinosa y presenta un modo de acción único, clasificado por el IRAC en el Grupo 5: activadores del receptor alostérico nicotínico de la acetilcolina.
Este modo de acción exclusivo reduce significativamente el riesgo de aparición de resistencias y no presenta resistencia cruzada con otros grupos insecticidas, lo que lo convierte en una herramienta clave en estrategias de rotación y manejo de resistencias.
Características técnicas
Spintor® 480 SC presenta un con-

junto de propiedades que lo hacen especialmente adecuado para su uso en agricultura moderna:
• Alta eficacia insecticida frente a orugas y trips, incluyendo nuevas especies invasoras.
• Bajo impacto sobre fauna auxiliar, permitiendo su integración en programas de Producción Integrada.
• Aprobado para Agricultura Ecológica, cumpliendo con normativas europeas y protocolos de certificación.
• Excelente perfil toxicológico y medioambiental, con baja toxicidad para mamíferos y escasa persistencia en el medio.
• Trazabilidad garantizada mediante la marca Qalcova™ active, que certifica el origen y calidad del ingrediente activo.
Aplicaciones globales y registro Qalcova™ active está registrado en más de 50 países y se utiliza en más de 250 cultivos a nivel mundial. Su eficacia ha sido validada frente a múltiples órdenes de insectos (Lepidoptera, Diptera, Coleoptera y Thysanoptera), lo que refuerza su versatilidad y aplicabilidad en distintos sistemas agrícolas.
SPINTOR




Resultados de eficacia frente a trips emergentes Corteva™ Agriscience ha llevado a cabo ensayos de laboratorio y campo para evaluar la eficacia de Spintor® 480 SC frente a especies de trips recientemente introducidas en España:
• Thrips parvispinus: se ha observado una excelente actividad a las dosis de registro en condiciones de laboratorio. Los ensayos de campo también han confirmado su alta eficacia, siempre que se asegure una correcta calidad de aplicación y cobertura foliar. Los ensayos de campo han demostrado que la calidad de la aplicación y la buena cobertura foliar son fundamenta-
les para conseguir un buen control de la plaga, ya que este trips se suele encontrar en el envés de las hojas desde las basales hasta las apicales.
• Scirtothrips aurantii: los ensayos de campo realizados en la Comunidad Valenciana (IVIA: Instituto Valenciano de Investigaciones Agrarias) durante 2024 y 2025 han demostrado una eficacia consistente y una persistencia adecuada. Los ensayos de laboratorio realizados sobre esta especie determinan que Spintor® 480 SC tiene un efecto muy potente, alcanzando controles totales de la plaga en esas condiciones de laboratorio.
• También se ha evaluado su eficacia frente a otras especies como Scirtothrips dorsalis y Chaetanaphothrips orchidii, con resultados positivos.
Consideraciones sobre la plaga y la correcta aplicación de productos fitosanitarios en campo Las especies Thrips parvispinus y Scirtothrips dorsalis, a diferencia de Frankliniella occidentalis, presentan una preferencia por habitar en hojas y frutos, refugiándose frecuentemente en zonas de difícil acceso como los puntos de contacto entre frutos, hojas y tallos. Esta particularidad biológica hace imprescindible implementar
un sistema de monitoreo riguroso y frecuente que permita una detección temprana de la plaga. La toma de decisiones debe ser rápida y basada en criterios técnicos sólidos, con el objetivo de evitar daños significativos en la producción, especialmente en los frutos, donde estas especies generan un impacto económico considerable.
Asimismo, la eficacia de los tratamientos fitosanitarios depende en gran medida de la calidad de la aplicación. Es fundamental utilizar herramientas de pulverización adecuadas, prestando especial atención a las boquillas y las presiones, que aseguren una cobertura homogénea y permitan alcanzar a los insectos en sus zo-
nas de resguardo. Una aplicación deficiente puede comprometer el control de la plaga, incluso cuando se emplean productos con alta eficacia comprobada.
Conclusiones
Spintor® 480 SC representa una solución innovadora, eficaz y sostenible para el control de trips, incluyendo especies emergentes como Thrips parvispinus y Scirtothrips sp... Su modo de acción único, su compatibilidad con la agricultura ecológica y su bajo impacto ambiental lo convierten en una herramienta indispensable en programas de manejo integrado de plagas y estrategias de prevención de resistencias.

Los productos de esta empresa son un símbolo de calidad y compromiso con el agricultor y la sostenibilidad
fh almería
La campaña agrícola 2025/2026 en la provincia de Almería ha comenzado marcada por la masiva presencia de Thrips parvispinus, una plaga que comenzó a tener presencia notable en el año 2022, y que actualmente es el principal problema de los agricultores de pimiento en Almería. Esta plaga, que tiene una gran capacidad para reproducirse, provoca numerosos daños en la planta, llegando incluso a detener el ciclo vegetativo de la misma, lo que provoca pérdidas de producción. Además, también pueden generarse graves deformaciones que deprecian el valor comercial de los frutos.
Dicho esto, Ecotrampa se enmarca como la empresa líder en fabricación de trampas de calidad para el control de plagas. Ecotrampa cuenta con una amplia gama de trampas o placas cromáticas que atrapan a los diferentes insectos que puedan amenazar los cultivos. La utilización de las trampas de colores otorga al agricultor la capacidad de anticiparse a la presencia de plagas en la finca, dando información sobre su nivel poblacional. Asimismo, es una excelente herramienta de combate, de fácil instalación y ecológica.
Los diferentes colores de las placas cromotrópicas están pensados para atraer determinados

insectos. Estos, atraídos por su color, se depositan sobre el material quedando atrapados por el adhesivo.
Así, Ecotrampa ha observado que la combinación de trampas amarillas y azules es una gran fórmula para capturar al Thrips. Estas trampas son las más efecti-










para el control de la mosca blanca, Thrips, pulgón, minadores, dípteros y moscas esciáridas, entre otros. Por otra parte, para el control de Tuta absoluta (minador de tomate), la empresa ofrece las placas de color negro, y para el monitoreo de Empoasca vitis o mosquito verde, presente en ocasiones en cultivos del Poniente almeriense, se aconsejan las trampas de color burdeos.
vas frente a este insecto que tanta preocupación está generando en Europa y cuya tipología previa (Frankliniella occidentalis) ya se conocía como un viejo enemigo de los agricultores almerienses. Es importante destacar que las trampas azules y la amarillas son las más utilizadas en Almería



Cada vez son más los agricultores que apuestan por los productos de Ecotrampa, y es que cuentan con una alta calidad del material del adhesivo que hace que, incluso con altas temperaturas, no se desprende.
Expansión y sostenibilidad
Ecotrampa ha culminado su primera fase de expansión con una fábrica de 2.500 metros cuadra-
dos. Con esta ampliación se ha conseguido automatizar los procesos lo máximo posible y de esta manera conseguir una mayor productividad, cubriendo así todas las necesidades que demanda el campo.
Ecotrampa tiene como proyecto para los próximos años, una segunda fase de crecimiento para ampliar la fábrica con un nuevo módulo de reciclaje, el objetivo es cerrar el ciclo de las trampas, es decir, una vez que el agricultor ha hecho uso de la Ecotrampa y acaba la vida útil de la misma, la propia empresa se encarga de reciclarlas y transformarlas en palets de plástico. Todo este proyecto ubicado en una parcela industrial de más de 10.000 metros en Alhendín (Granada), donde Ecotrampa tiene la actual fábrica.






La llegada de este trips se ha tornado en uno de los grandes desafíos actuales del control biológico, ya que los fitosanitarios químicos no lo controlan y destruyen el equilibrio biológico
El Thrips parvispinus se ha convertido en las últimas campañas en uno de los principales temores del agricultor almeriense. Y es que son muchos ya los que se han visto obligados a arrancar hectáreas completas a causa de una plaga que, además, parece intensificarse año tras año.
Su ciclo biológico se completa en apenas 12 o 15 días a 25–30 °C; y, mientras las larvas se alimentan en hojas y flores, las pupas se desarrollan en el suelo. Provoca plateado y deformaciones en hojas y frutos; cicatrices rugosas profundas en pimiento; y decoloraciones y deformaciones apicales en pepino.
Unos daños que, junto a la rápida expansión de este trips, ha provocado que el control biológico vea ante sí un gran desafío en los cultivos hortícolas bajo invernadero del sureste español, especialmente en pimiento y pepino.
Esta especie, originaria del sudeste asiático, se adaptó rápidamente a los cultivos de clima cálido, provocando daños severos en hojas, flores y frutos. Además, a diferencia de otros trips, el Thrips parvispinus muestra una elevada resistencia a insecticidas y una gran capacidad de ocultación, lo que dificulta su control con métodos tradicionales.
Sin embargo, Koppert ya ha desarrollado un protocolo específico basado en la integración de depredadores, microorganismos y medidas culturales, con resultados positivos incluso en condiciones de verano.
Según Julián Giner, director técnico de Koppert, ante la situación actual de alta presión de Trips parvispinus en los cultivos de pimiento de Almería, uno de los principales puntos de mejora frente a él es el momento en el que hacemos las sueltas de enemigos naturales. “Estamos soltando los bichos tarde”, erigía basándose en la experiencia de “las fincas que estamos asesorando de manera directa por parte de nuestro equipo técnico”.

Y es que, según Giner, los agricultores de pimiento están acostumbrados a hacerlo en la quinta o sexta semana; cuando ahora hay que hacerlo en la tercera. “Este cambio conlleva tener que realizar menos tratamientos químicos al inicio del cultivo, con la idea de tener poblaciones de enemigos naturales altas antes de que la plaga se encuentre fuera de control. En ese momento, ya no funciona”, razonaba.
Por ello, el director técnico de Koppert ha enumerado los principales pasos a seguir en la batalla contra el parvispinus. Plan que, si se sigue, “logra controlar este trips al 100%”, asegura. “Tenemos que hacer limpieza total del invernadero antes del trasplante; eliminar las malas hierbas y restos vegetales; instalar mallas anti-insectos y doble puerta; mantener la humedad relativa superior al 60%; llevar a cabo un monitoreo con trampas azules; y realizar sueltas tempranas de fauna auxiliar con apoyo microbiológico”. De esta forma, se conseguiría controlar en gran medida al gran enemigo del campo almeriense,

que, como coinciden la mayoría de expertos, se comporta de forma diferente al resto de trips.
Para conocerlo bien, Julián Giner ha recalcado que es necesario saber que el Thrips parvispinus actúa de forma gregaria. Destruye los estambres y el pistilo de las flores y deja a las plantas sin polen. Además, se esconde en el pedúnculo; por lo que se ‘protege’ de la acción de armas como el Orius.
Esto se convierte así en un hecho clave, ya que dicho Orius laevigatus necesita polen y humedad media-alta para reproducirse. Cuando el parvispinus daña las flores, éstas quedan sin néctar ni polen, por lo que se impide su instalación; al igual que ocurre con humedades inferiores al 60%, donde las hembras de Orius dejan de poner huevos y las poblaciones colapsan.
“Hablando de ácaros, nuestra mejor opción, Amblydromalus limonicus, no necesita polen. Se alimenta de Larvas L1 y L2 y también de huevos de parvispinus, tolera baja humedad y mantiene actividad depredadora durante el verano, colonizando el cultivo antes de floración.
“La introducción temprana de limonicus permite romper el ciclo de la plaga y mantener poblaciones bajas durante todo el cultivo”, argumenta Giner, quien ha aclarado que este depredador es la mejor opción contra el parvispinus. “Es un círculo vicioso. Los productos químicos convencionales no controlan la plaga, ya que parvispinus ha desarrollado resistencia a ellos y empeoran el equilibrio biológico”, apunta.
En definitiva, según defiende el director técnico de Koppert, “el éxito depende de una combinación precisa de medidas culturales, fauna auxiliar, microorganismos y una introducción de ácaros depredadores antes de la floración (3ª semana), ya que “no existen fitosanitarios, que funcionen contra el parvispinus”. “Debemos hacer un cambio de mentalidad y saber que, contra este Trips parvispinus, los procedimientos de antes ya no sirven”, advertía Julián Giner.
Thrips parvispinus
La coordinadora lamenta la falta de avances ante las plagas que asolan el campo. Alertan de la presencia de trips y de araña roja en otros cultivos a los que ya se están extendiendo
La Coordinadora de Organizaciones de Agricultores y Ganaderos (COAG) de Almería ha lanzado un comunicado en el que lamenta la falta de avances en la implementación de soluciones urgentes ante el grave problema de plagas que están afectando los cultivos. Especialmente hacen referencia a los daños en pimiento, aunque explican que ya se está extendiendo a otros. Una gravedad que ejemplifican con el caso del parvispinus, ya que afirman que el cien por cien de los frutos de pimiento están dañados por este insecto.
Andrés Góngora Belmonte, secretario Provincial de COAG Almería, ha señalado que el grupo

Frutos de pimiento dañado por parvispinus. /J. V. S.
técnico, creado hace un mes, a iniciativa de la Consejería de Agricultura de la Junta de Andalucía, con voluntad de aportar respuestas eficaces, “no está regis-
trando progresos significativos” en un momento que se considera “crucial” para el sector.
Así, en la segunda reunión del Grupo Técnico de Expertos en Sa-
nidad Vegetal, que tuvo lugar a mediados del mes de octubre, COAG Almería tomó parte activa desde su inicio con el objetivo de afrontar de forma coordinada la situación generada por las plagas que afectan a los cultivos de la provincia, especialmente Thrips parvispinus y la araña roja. Sin embargo, no llegaron a ponerse en práctica las medidas que el campo almeriense necesita y que, desde COAG Almería se llevan reclamando desde hace más de un mes, como única solución para amortiguar el impacto de las plagas, como por ejemplo: la solicitud de autorizaciones excepcionales de las materias activas, propuestas por el equipo técnico, que todavía no ha sido tramitada ante el Ministerio de Agricultura.
Así las cosas, la coordinadora recuerda que las propuestas planteadas hasta ahora, centradas en el control biológico o en medidas preventivas, resultan insuficientes ante una situación de emergencia. COAG Almería recuerda que la petición de tramitar, por parte de la Consejería ante el Ministerio de Agricultura las autorizaciones excepcionales, fue presentada desde el inicio de la actividad del Grupo Técnico, incluyendo también los productos necesarios para la desinfección de las infraestructuras tras el arranque de cultivos afectados. “A día de hoy, esta solicitud aún no ha sido atendida”, informa Góngora, quien ha insistido en que “sin estas herramientas, no tenemos capacidad para actuar con eficacia”.









• Control efectivo de todo tipo de TRIPS, incluidos los nuevos Trips
• Control eficaz contra todo tipo de ORUGAS
• Modo de Acción Único frente a TRIPS y ORUGAS, clasificado en IRAC Grupo 5
• Corto Plazo de seguridad
• Calidad y Composición Garantizadas
• Compatible con Control Biológico y Producción Integrada
Visítanos en: corteva.com/es | @cortevaES
Esta información podría no estar actualizada. Con el fin de evitar riesgos para las personas y el medioambiente, lea atentamente la